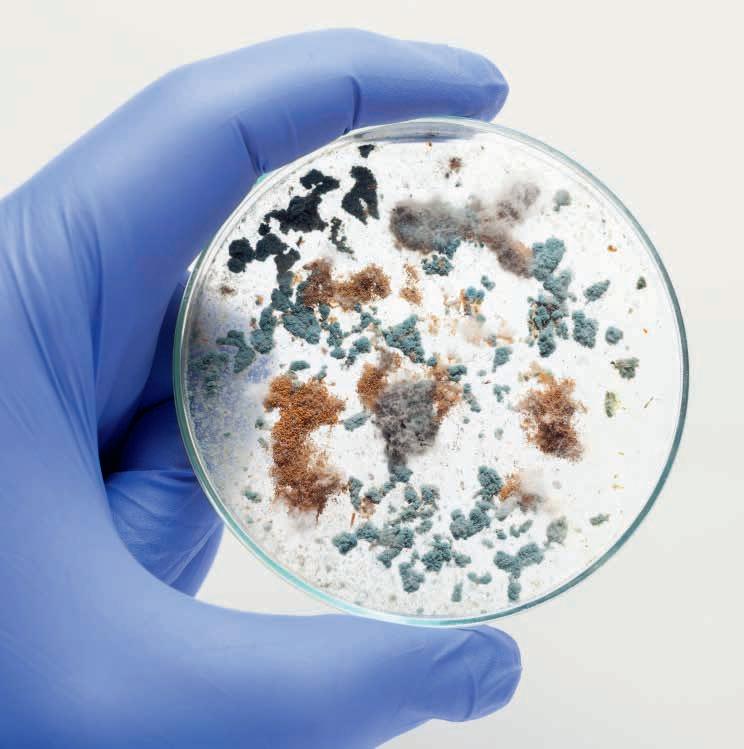

Festtage
Mit Kindern Güetzi backen macht Freude
Wenn der Rücken drückt
Die Arbeit rückenfreundlich gestalten

![]()
Festtage
Mit Kindern Güetzi backen macht Freude
Wenn der Rücken drückt
Die Arbeit rückenfreundlich gestalten

Stark und doch sensibel
Dorn-Therapie
Die Wirbelsäule wieder ins Lot bringen
Urin
Taugt der Körpersaft als Heilmittel?










































































































Liebe Leserin, lieber Leser
Nicht umsonst spricht man davon, «jemandem den Rücken zu stärken» oder «den Rücken freizuhalten». Schliesslich ist unsere Wirbelsäule ein wahres Wunder und von fundamentaler Bedeutung für unseren Körper. Sie stützt und stabilisiert uns nicht nur von Kopf bis Fuss, sie verbindet auch alle unsere Knochen und Nerven. Es ist also unmöglich, unsere Wirbelsäule isoliert vom restlichen Körper zu betrachten. Einen genaueren Blick darauf, welche Wirbel mit welchen Körperteilen verbunden sind, werfen wir im Artikel «Wunderwerk Wirbelsäule», in dem insbesondere die Wirbeltherapie nach Dorn im Zentrum steht.
Je mehr wir über die Bedeutung des Rückens erfahren, desto klarer wird es, dass wir unserem Rücken Sorge tragen müssen. Rückenschmerzen sind in der Schweizer Bevölkerung weit verbreitet und haben in den letzten Jahren gar zugenommen. Vor allem bei der Arbeit lässt sich durch die richtige Haltung schon viel erreichen. Auch dafür haben wir Ihnen in diesem Heft einige wertvolle Tipps zusammengestellt. Wenn Ihre Verspannung weiter anhält, dann könnten Sie in der Pohltherapie Hilfe finden. Eine noch nicht so bekannte Therapieform, die wir Ihnen auf den nächsten Seiten etwas genauer vorstellen werden.
Jetzt wo die Tage wieder kürzer werden und die Temperaturen sinken, haben wir Ihnen nicht nur Ausflugstipps für verschneite Tage bereit, sondern wir zeigen Ihnen auch, wie Sie Ruhe und Kraft tanken können. Steven Wolf stellt Ihnen den uralten Brauch des Neunerleiholzes vor, das Ihnen im Winter Schutz und Wärme spendet. Und auch etwas Weihnachtsstimmung kommt auf in unserer aktuellen Ausgabe: Wir zeigen Ihnen wie das «Guetzlen» mit Gross und Klein zu einem Erfolg wird.
In diesem Sinne wünsche ich Ihnen frohe Festtage und alles Gute für das neue Jahr. Ich hoffe, Sie können diese Zeit, trotz zeitweiliger

Es ist nie zu spät sich für die kalte Jahreszeit zu rüsten.
Zellavie® Wintersonne mit 1,3/1,6 Beta-Glucan aus Hefe stärkt das Immunsystem Beta-Glucan


Weniger Erkältungen
Geringere Grippeanfälligkeit
Mildere Verläufe
Beta-Glucan aus Hefe aktiviert beim Menschen körpereigene Abwehrzellen. Zellavie® Wintersonne stärkt das Immunsystem, deine Muskeln, Knochen und Zähne – vollkommen natürlich und wissenschaftlich belegt.

Jetzt bestellen auf zellavie.ch


So finden Sie qualifizierte Naturheilpraktiker:innen
Seit über 20 Jahren zeichnet das ErfahrungsMedizinische Register EMR qualifizierte, erfahrene Therapeut:innen der Komplementär- und Alternativmedizin mit dem EMR-Qualitätslabel aus – für fast alle Krankenversicherer auch die Grundvoraussetzung, um deren Leistungen zu vergüten.
Finden auch Sie Therapeut:innen mit EMR-Qualitätslabel ganz einfach mit der Suchfunktion auf emr.ch
Mehr zum EMR erfahren Sie aus der Publireportage in diesem Heft


GESUND SEIN
10 Rückenkiller Bürostuhl
Viele Arbeitsplätze sind nicht optimal für den Rücken.
14 Dorn-Wirbeltherapie
Es lohnt sich, sich die Wirbel zu richten.
26 Sabine Hurni über … … das Zentriertsein.
GESUND WERDEN
32 Pohltherapie
Fünf Techniken, um Verspannungen zu lösen.


36 Urin-Therapie
Nicht nur Naturvölker setzen auf Heilkraft des Urin.
40 Neunerleiholz
Wie Sie Licht in den Herbst bringen können.
DRAUSSEN SEIN
48 Biodiversität
Was wir im Garten für Artenvielfalt tun können.
52 Malferien am Meer
Kommen Sie mit uns auf unsere Leserreise.
56 Gleiten statt Hetzen Langlauf im Oberengadin entschleunigt.
03 Editorial / 06 Leben und Heilen / 24 Rezept / 31 Liebesschule
44 Staunen und Wissen / 63 Hin und weg / 63 Neu und gut / 64 Rätsel / 65 Vorschau / 66 Eva unterwegs EntdeckenSie dasRezeptder Bratapfel-Kekse
Jetzt einkaufen und erleben: www.jentschura-shop.ch

FORSCHUNG
Die optimale Schlafdauer unterscheidet sich von Mensch zu Mensch. Forschende haben nun untersucht, wie Erkrankungen, Lebenserwartung und Schlaf zusammenhängen. Wie viele Stunden pro Tag der Mensch schlafen sollte, lässt sich pauschal schwer sagen, denn das Schlafbedürfnis ist sehr individuell. Dennoch gibt es einige Punkte, die sich verallgemeinern lassen, schreibt «watson.ch». Französische und britische Forschende haben dazu genauer untersucht, inwieweit die Schlafdauer Einfluss auf die Entstehung einer oder mehrerer chronischer Erkrankungen und die allgemeine Sterblichkeit hat. Die Auswertung der Schlafdauer der 50- bis 70-jährigen Frauen ergab, dass sich die meisten Probandinnen etwa sieben Stunden zur Nachtruh begaben, gefolgt von sechs und acht Stunden pro Nacht. Einige der Teilnehmerinnen schliefen mit einer Dauer von fünf Stunden oder weniger auch deutlich weniger. Am seltensten schliefen die 50- bis 70-Jährigen länger als neun Stunden pro Nacht. Eine kurze Schlafdauer von fünf oder weniger Stunden pro Nacht ist im Vergleich zur Schlafdauer von sieben Stunden mit einem 20 Prozent höheren Risiko verbunden, eine chronische Erkrankung zu entwickeln. Auch die Wahrscheinlichkeit, nach der ersten Erkrankungen noch weitere zu entwickeln, steigt um 20 Prozent. Es besteht also ein klarer Zusammenhang zwischen Schlafmangel und Multimorbidität. ska


PHYSIOTHERAPIE
Immer mehr Physiotherapeut*innen in der Schweiz
In der Schweiz arbeiteten im Jahr 2020 rund 18 000 anerkannte Physiotherapeutinnen und -therapeuten. Das sind im ambulanten Bereich knapp 36 Prozent mehr als noch im Jahr 2013. Das schreibt «Physio Swiss» in einem neuen Faktenblatt. «Trotzdem macht die Physiotherapie mit rund drei Prozent immer noch nur einen Bruchteil der Gesundheitskosten aus», heisst es weiter. Rund zwei Millionen Menschen in der Schweiz würden an einer Erkrankung des Bewegungsapparates leiden. Sogar knapp fünf Millionen Menschen seien in den letzten fünf Jahren in physiotherapeutischer Behandlung gewesen. Dabei geben laut einer GFS-Umfrage rund 90 Prozent der Menschen an, die Physiotherapie habe ihnen einen direkten Nutzen gebracht. 70 Prozent geben an, ihre Situation habe sich verbessert, und noch einmal 23 Prozent haben eine Stabilisierung festgestellt. «Physio Swiss» kritisiert aber auch den geltenden Taxpunktwert für Physiotherapie. Dieser sei seit 1996 nur um 8,5 Prozent erhöht worden, während gleichzeitig die Kosten für den Praxisbetrieb um rund 25 Prozent gestiegen seien. ska

WELTGESUNDHEITSORGANISATION
WHO warnt vor lebensgefährlichen Pilzinfektionen
Die Weltgesundheitsorganisation (WHO) ist besorgt über 19 krankheitserregende Pilze, die nach Expertenansicht die öffentliche Gesundheit bedrohen.
Diese Erreger müssten besser erforscht werden, um Behandlungsmöglichkeiten zu entwickeln, berichtete die WHO gemäss dpa. Pilzerkrankungen seien für manche Menschen lebensgefährlich. Sie erhielten aber zu wenig Beachtung. Es sei unbekannt, wie viele Menschen betroffen seien. Die Überwachung müsse verbessert werden, aber man könne nicht warten, bis Zahlen vorliegen, warnt die WHO. Sie nennt unter anderem den Pilzerreger Candida auris, der vor allem Patient*innen in Kliniken befällt und gegen viele Wirkstoffe resistent ist.
Er wurde erst 2009 in Japan entdeckt, sei aber bereits in mehr als 50 Ländern verbreitet. «Für die meisten Pilzerreger gibt es keine schnellen und sensitiven Diagnostika, und die vorhandenen sind weltweit weder allgemein verfügbar noch erschwinglich», teilte die WHO mit. ska
























Ganzheitliche Krebsbehandlung




Ihre kostenlose Broschüre unter www.iscador.ch/gkb1122
Erfahren Sie mehr über die Ursachen und integrativen Behandlungsmöglichkeiten von Krebserkrankungen.


PFADI
Wer an einem Lager teilnimmt, stärkt damit seine psychische Gesundheit. Zu diesem Schluss kommt eine Studie, die unter Pfadis im Bundeslager im Goms durchgeführt wurde. Die Pfadibewegung Schweiz hat gemäss «blick.ch» untersuchen lassen, ob ihre Aktivitäten eine positive Wirkung haben. Rund 650 Jugendliche zwischen 14 und 17 Jahren füllten im Pfadibundeslager (BuLa) im Goms VS im vergangenen Sommer einen Fragebogen der Pädagogischen Hochschule Zürich aus.
Einmal zu Beginn, einmal zum Ende des zweiwöchigen Grossanlasses. Mitfinanziert durch die Pfadibewegung Schweiz untersucht die Studie, ob gemeinsame Lageraktivitäten das Wohlbefinden – und damit auch die psychische Gesundheit – junger Menschen fördern. Die Resultate sind für die Pfadi erfreulich: Vom ersten bis zum zweiten Messzeitpunkt hatten sich die positiven Emotionen bei den befragten Pfadfinderinnen und Pfadfindern erhöht. Die Euphorie, welche die Pfadis während des BuLas erlebten, spiegelt diese Ergebnisse. ska


GESUNDHEITSPREIS
Die 2015 eingeführte Weiterbildung zur medizinischen Praxiskoordinatorin bzw. zum Praxiskoordinator (MPK) erfüllt die Erwartungen der Ärzteschaft. Dies zeigt ein Bericht, den der Bundesrat an seiner Sitzung vom 26. Oktober 2022 verabschiedet hat. Seit 2015 können sich medizinische Praxisassistentinnen und Praxisassistenten (MPA) mit einer Fachprüfung zur MPK weiterbilden. Bis Ende 2021 haben 793 Personen die Weiterbildung absolviert. Die Weiterbildung mit eidgenössischem Fachausweis ist bei medizinischen Praxisassistentinnen und Praxisassistenten (MPA) beliebt und trägt zur Qualität der Versorgung bei, schreibt das Bundesamt für Gesundheit (BAG) in einer Mitteilung. Diese Einschätzung wird durch eine 2021 durchgeführte Studie des Berner Hausarztinstituts (BIHAM) gestützt. Sie zeigt, dass der Einsatz von MPK in Hausarztpraxen zum Erhalt der Versorgungsqualität beitragen kann, und dass gewisse Leistungen von den MPK in derselben Qualität durchgeführt werden können, wie wenn diese durch die Hausärztin oder den Hausarzt erbracht werden. ska


Acerola Kirschen Kapseln sind die reichhaltigsten natürlichen Vitamin CSpender.
Acerola Kirschen
Dose 60 g120 Kapseln, Art.Nr.7617,Fr.42.00 plus

Mit Kräuterkapseln den Darm in Bewegung bringen. Zur täglichen Versorgung mit wertvollen Ballaststoffen.
Super Co - Balance,
Dose 100 g200 Kapseln, Art.Nr.0268,Fr.62.75
Nahrungser
Die Beliebtheit und Wertschätzung von Zimt basiert auf der Jahrtausende alten ayurvedischen Tradition.
ZimtkapselnDose 59 g 90 Kapseln,Art.Nr.7221Fr.35.75 plus

Glucosamin
Dose 88 g120 Kapseln Art.Nr.6121Fr.67.50 plus Glucosamin ist ein Bestandteil der Knie- und Rückenknorpel.
Optimal bei erhöhter körperlicher und geistiger Anstrengung für alle Generationen.

In Gelée Royale sind alle wichtigen Substanzen und Aufbaustoffe enthalten. Als effiziente Aufbau- und Zusatznahrung hat Gelée Royale ein sehr breites Anwendungsspektrum. Jedermann, ob jung oder alt kann von der ausgezeichneten und effizienten Wirkungsweise von Gelée Royale profitieren.
Gelée RoyalBox mit 20 Ampullen200 ml Art.Nr.7026,Fr.56.25
Spezial – Angebot für Leser und Leserinnen von «natürlich»

Das Spezialangebot gilt für alle Produkte unseres Sortimentes. Besuchen Sie deshalb jetzt unseren Shop www.prosana.ch Es lohnt sich!
Mindestbestellwert Fr. 100.-, Angebot gültig bis 31 12.2022
Versandkostenanteil
Vorname Name Strasse / Nr. PLZ / Ort
Datum Unterschrift
E-Mail Adresse
Bitte senden Sie mir gratis den ausführlichen Produktekatalog
Ganze Seite oder Bestellschein in Couvert stecken und einsenden an: pro sana GmbH,Hauptstrasse 64,CH-4153 Reinach

Jede vierte Person fühlt sich durch Rückenbeschwerden bei der Erwerbstätigkeit beeinträchtigt. Neben dem zu langen Sitzen gehören falsch eingestellte Büromöbel und einseitige sowie falsche Bewegungen zu den Ursachen.
Fabrice Müller
Jeden Morgen um 7.15 Uhr wird bei Stadtgrün Luzern geturnt. Und das bereits seit zehn Jahren. «Wir waren und sind immer noch überzeugt, dass dies für unsere Mitarbeitenden eine positive Sache ist», sagt Otto Helfenstein, stellvertretender Ressortleiter Zentrale Dienste. Je nach Platzverhältnissen findet das Turnen im oder um eines der Depots des Stadtgrüns statt. (Siehe links) Einige Mitarbeitende übernehmen dabei abwechslungsweise das Vorturnen. Otto Helfenstein ist von der Wirkung des morgendlichen Turnens überzeugt: «Viele Mitarbeitende sind dadurch sensibler für Gesundheitsthemen geworden. Sie befassen sich auch in der Freizeit mehr mit Bewegung und dem Thema Gesundheit.» Die Reaktionen seien durchwegs positiv. Offenbar schätzen die Mitarbeitenden des Stadtgrüns die Zeit, die sie am Morgen in ihre Gesundheit investieren. Auf diese Weise konnten die für ihren Beruf typischen Beschwerden wie Rücken-, Schulter-, Handgelenk-, Hüft- und Knieprobleme reduziert werden.
215 Millionen Stunden Arbeitsausfälle
Rückenschmerzen sind in der Schweiz weit verbreitet und betreffen alle Altersgruppen und Berufe, wie der Rückenreport Schweiz 2020 der Rheumaliga Schweiz ergeben hat. Die Umfrage zeigt, dass 88 Prozent der Befragten in ihrem Leben bereits einmal an Rückenschmerzen gelitten haben. Frauen und sozioökonomisch schlechter Gestellte sind laut dem Rückenreport häufiger von Rückenproblemen betroffen. Jede vierte Person fühlt sich durch Rückenbeschwerden offenbar bei der Erwerbstätigkeit beeinträchtigt. Etwas weniger als ein Drittel der Betroffenen ist aufgrund von Rückenschmerzen bereits einmal am Arbeitsplatz ausgefallen. Laut den Zahlen des Bundesamtes für Statistik (BFS) erhöhten sich die Absenzen am Arbeitsplatz zwischen 2007 und 2017 von 176 auf 215 Millionen Stunden. Diese gehen mehrheitlich auf Erkrankungen des Muskel- und Skelettsystems wie Rückenschmerzen zurück.
«
Viele Mitarbeitende sind dadurch sensibler für Gesundheitsthemen geworden. »
Wir sitzen zu lange!
Für Barbara Zindel, diplomierte Physiotherapeutin FH mit einer ergonomischen Zusatzausbildung und zuständig für Projekte bei der Rheumaliga Schweiz, liegen die Ursachen für Rückenprobleme am Arbeitsplatz vor allem beim Menschen selber: «Viele, die im Büro arbeiten, sitzen zu viel – zuerst im Beruf, während des Pendelns im öffentlichen Verkehrsmittel oder Auto und dann abends auch noch zuhause vor dem Bildschirm.» Wie eine Studie des BFS ergeben hat, verbringen die 15- bis 74-Jährigen im Durchschnitt vier bis fünf Stunden pro Tag im Sitzen. Ein Sechstel der Befragten verharrt sogar mehr als 8,5 Stunden täglich in dieser Position.
Das lange Sitzen löst – so Barbara Zindel – muskuläre Beschwerden in den Beinen wie auch im Rücken sowie die Gefahr von Herzkreislauferkrankungen aus. Vor allem die Sauerstoffzufuhr und der Blutfluss verlangsamen sich beim Sitzen, was sich schlussendlich schädlich auf die Muskulatur und Gelenke auswirkt. «80 bis 90 Prozent der Rückenschmerzen sind auf ein muskuläres Ungleichgewicht vor allem im Bauch- und Rückenbereich zurückzuführen.» Laut Studien aus den USA lässt sich zu langes Sitzen am Arbeitsplatz auch nicht durch Sport am Abend kompensieren.

Zwischen Ober- und Unterschenkel sowie zwischen Oberschenkel und Rumpf sollte ein Winkel von 90 Grad oder etwas grösser sein.

Um den Rücken während des Büroalltags zu entlasten, wird empfohlen, regelmässig aufzustehen, sich zu strecken und einige Schritte zu laufen.
Neben Büroangestellten sind auch Personen von Haltungsbzw. Rückenschäden betroffen, die vor allem körperlich arbeiten. Menschen, die an Fliessbändern arbeiten, leiden laut Barbara Zindel häufig an Rückenschmerzen und Krampfaderproblemen, die durch das lange Stehen hervorgerufen werden. Eine Sitz-Steh-Hilfe würde die Rückenmuskulatur entlasten, ebenso ergonomische Fussmatten mit einer dämpfenden Wirkung. «Repetitives Arbeiten führt oft zu Fehlhaltungen», ergänzt die Physiotherapeutin. Bei Lastwagen- und Buschauffeure hingegen mache sich das lange Sitzen in Form von Beschwerden am Rücken, vor allem im unteren Rücken, bemerkbar. Barbara Zindel rät, das Sitzen regelmässig mit Gehpausen und kleinen Bewegungsübungen sowie Dehnungen zu unterbrechen, um den Rücken zu entlasten.
Das Heben von schweren Gewichten birgt weitere Gefahren für den Rücken. Um kleine Gewichte zu heben, dürfe man schon mal den Rücken beugen, sollte sich jedoch mit der einen Hand am Oberschenkel abzustützen, erklärt Barbara Zindel. Doch ab ca. fünf Kilogramm sollte man auf eine korrekte Haltung achten. Das heisst: Heben mit geradem Rücken und gebeugten Knien. Eine gute Hebetechnik schont nicht nur die Bandscheiben, sondern den ganzen Bewegungsapparat. Sie hat zusätzlich einen gewissen Trainingseffekt und stärkt die Muskulatur. Je weiter man sich indes nach vorne beugt und je grösser das Gewicht, umso grösser ist die Belastung der Bandscheiben. «Deshalb sollte man schwere Lasten stets ums Eck anheben», ergänzt Barbara Zindel und rät, das Gewicht nahe an sich zu nehmen und sich mit dem Gegenstand zu drehen. (fm)

Der Wechsel zwischen Sitzen und Stehen wirkt sich auf den Rücken grundsätzlich positiv aus.
Ein weiteres Problem liege bei der unsachgemässen Anwendung von Büromöbeln. «Ich habe über 2000 Büros besucht und beraten. Dabei stellte ich vielerorts fest, dass Bürostühle, Tische und Stehtische in vielen Fällen nicht richtig eingestellt sind.» Obwohl in vielen Büros Stehtische angeschafft wurden – oft auch auf Wunsch der Mitarbeitenden selbst –, beobachte die Mitarbeiterin der Rheumaliga Schweiz, dass die Tische nur selten im Stehen genutzt werden.
Ein weiteres Beispiel: Dynamisch einstellbare Rückenlehnen von Bürostühlen bleiben häufig ungenutzt, weil viele der Büroangestellten gar nicht wissen, wie man diese Zusatzfunktionen richtig aktiviert. Das Problem einer schlechten Haltung und unergonomischer Büromöbel habe sich im Zuge des Home-OfficeTrends zusätzlich verstärkt.
Schon seit Jahren ist das Angebot an «ergonomischen» Büromöbeln gross. Doch sind ergonomische Büromöbel, die zum Beispiel ein dynamisches, bewegtes Sitzen ermöglichen, oder höhenverstellbare Tische, an denen man auch im Stehen arbeiten kann, des Problems Lösung? Nur bedingt, findet Barbara Zindel. Wichtig sei, dass man die Möbel korrekt einstellen und bedienen kann. Von Bürostühlen ohne Rückenlehne etwa hält sie wenig: «Es braucht eine dynamisch verstellbare und auch fixierbare Rückenlehne, damit sich die Rückenmuskulatur beim Anlehnen immer wieder entlasten kann.» Auf diese Weise unterstütze der Bürostuhl die Angestellten in allen Sitzhaltungen. Ein weiterer wichtiger Faktor beim Bürostuhl sei die Sitztiefe: Der Abstand zwischen Stuhlkante und Kniekehle dürfe nicht mehr oder weniger als zwei Fingerbreiten umfassen. Ist der Abstand grösser, besteht laut
Unterarmstütz: Das Stärken der Rücken- und Bauchmuskulatur wirkt präventiv gegen Rückenschmerzen.
Barbara Zindel die Gefahr eines krummen Rückens, weil die Oberschenkel zu wenig unterstützt werden und dadurch eine Fehlhaltung begünstigt wird. Liegt die Kniekehle eng an der Stuhlkante, werde die Blutzufuhr in die Beine zu stark abgeschnitten. Zwischen Oberund Unterschenkel sowie zwischen Oberschenkel und Rumpf sollte ein Winkel von 90 Grad oder etwas grösser sein. Da man beim dynamischen Sitzen verschiedene Muskelstrukturen, die Rückenmuskeln und auch Bauchmuskeln unterschiedlich und im Wechsel beansprucht, werden einseitige Belastungen vermieden. Gleichzeitig be- und entlastet man dadurch die Bandscheiben auf natürliche Weise. Dies wirkt sich positiv auf die Nährstoffversorgung der Bandscheiben aus. Und schliesslich erhöht das dynamische Sitzen die Durchblutung – vom Körper bis zum Gehirn.
Zu langes Stehen ist ungesund
Der Wechsel zwischen Sitzen und Stehen wirke sich auf den Rücken grundsätzlich positiv aus, sagt Barbara Zindel – doch: «Die Tische müssen leicht verstellbar sein, am besten elektrisch, sonst bleiben die Tischflächen meistens unten.» Die Physiotherapeutin empfiehlt, mindestens eine halbe bis Dreiviertelstunden pro Halbtag im Stehen zu arbeiten. Eine Studie der australischen Curtin University hat allerdings ergeben, dass selbst Stehtische für Büroangestellte nicht unbedingt die gesündere Alternative darstellen. Dafür beobachteten die Forschenden 20 Personen bei der Arbeit. Laut der Studie kann längeres Stehen die Gesundheit und Produktivität negativ beeinflussen. Die Studienteilnehmenden klagten über Muskelentzündungen und Schwellungen der Beine.
Tiefenmuskulatur stärken
Vom Körperbau her müsste der Mensch jeden Tag einige Kilometer weit gehen. Doch nur die wenigsten
sind dazu allein aus zeitlichen Gründen in der Lage. Trotzdem ist es laut Barbara Zindel wichtig, bewusst für genügend Bewegung zu sorgen. Um den Rücken während des Büroalltags zu entlasten, empfiehlt sie, regelmässig aufzustehen und einige Schritte zu laufen, sich zwischendurch zu strecken sowie Pausen und Kurzpausen bewusst einzuplanen. Das Stärken der Rücken- und Bauchmuskulatur wirke ebenfalls präventiv gegen Rückenschmerzen. Vor allem die Tiefenmuskulatur, nahe an den Gelenken gelegen, sollte trainiert werden, empfiehlt Barbara Zindel und schlägt dazu Sportarten wie etwa Pilates, Antara oder Yoga vor. «Allein die äusseren Muskeln zu trainieren, reicht nicht, weil sie dem Rücken nicht genügend Stabilität verleihen. Deshalb leiden zum Teil auch Bodybuilder*innen unter Rückenproblemen.»
www.rheumaliga.ch
www.suva.ch

Barbara Zindel, diplomierte Physiotherapeutin FH mit einer ergonomischen Zusatzausbildung und zuständig für Projekte bei der Rheumaliga Schweiz.

Beschwerden des Bewegungsapparates hängen häufig mit der Wirbelsäule zusammen. Es lohnt sich, die Wirbel regelmässig ins Lot zu bringen. Zum Beispiel mit der Wirbeltherapie nach Dorn.
Sabine Hurni
Mein Rücken fühlt sich an wie ein Brett. Irgendwo ganz unten, am Anfang der Wirbelsäule beginnt der Schmerz», seufzt Irene Schmid, die sich letztes Jahr selbständig gemacht hat. Im weiteren Gesprächsverlauf stellt sich heraus, dass sie Geldsorgen hat. «Ich weiss nicht, wie ich Ende Monat meine Rechnungen bezahlen soll», erzählt sie verzweifelt. Stress und Ärger im Beruf oder mit anderem Menschen geht nicht spurlos an der eigenen Psyche vorbei und zeigt sich auch in körperlichen Beschwerden. So sind laut Louise L. Hay, Autorin des Buches «Gesundheit für Körper und Seele», der Körper und die Psyche/Seele eng miteinander verwoben, weshalb es wichtig ist, die Behandlung auf beiden Ebenen anzusetzen. Bei Schmerzen im unteren Rücken ist laut Hay mit grosser Wahrscheinlichkeit das Geld ein Thema. Diese Erkenntnis spült Irene Schmid natürlich noch kein Vermögen auf ihr Konto. Wenn sie offen dafür ist, kann sie jedoch mit Louise L. Hays Affirmationen arbeiten und sich mehrmals täglich sagen: «Ich liebe und akzeptiere mich. Das Leben unterstützt und liebt mich». So kann sich eine Lösung ergeben, während sie gleichzeitig auf der Körperebene mit Entspannung und Wärme die Muskeln löst und die Wirbel in Balance bringt.
Meisterwerk Wirbelsäule
Unsere Wirbel sind übereinander angeordnet und bilden eine senkrechte Achse von insgesamt 32 bis 34 Wirbeln. Die Zahl variiert, weil das Steissbein aus drei bis fünf zusammengewachsenen Steissbeinwirbeln besteht. Identisch bei allen Menschen sind die sieben Halswirbel, die zwölf Brustwirbel, die fünf Lendenwirbel und die fünf, zum Kreuzbein zusammengewachsenen Kreuzbeinwirbel. Jeder Wirbel besteht aus einem Dornfortsatz, der nach aussen ragt und auf dem Rücken eine feine Kette zeichnet. Die Wirbel haben zwei Querfortsätze, ein Wirbelloch, durch das die Nervenstränge und Blutbahnen des Rückenmarks verlaufen und einen
Wirbelköper, der oben und unten mit einer weichen Bandscheibe vom nächsten Wirbelkörper getrennt ist. Zwischen je zwei benachbarten Wirbeln ist ein Loch, durch das die Rückenmarksnerven heraustreten. Sie haben eine direkte Verbindung zu den inneren Organen und versorgen sie mit Energie. Deshalb lässt sich die Wirbelsäule nicht isoliert vom restlichen Körper betrachten.
Falsche Bewegungen, einseitige Belastungen beim Sport oder im Alltag, ein Stoss oder ungleichlange Beine können dazu führen, dass ein Wirbel «herausrutscht». Auch verspannte Muskelgruppen, oft verursacht durch eine extreme Stresssituation, können einen oder mehrere Wirbel konstant in eine bestimmte Richtung ziehen und verursachen mit der Zeit leichte Verschiebungen eines Wirbels. Das fühlt sich noch nicht an wie ein Rückenklemmer oder ein Hexenschuss. Es handelt sich vielmehr um kleinste Fehlstellungen, die aber durchaus einen Einfluss auf die Energieversorgung des Körpers haben können. Was war zuerst? Der Stress, der verschobene Wirbel, die Zugluft oder die
Wirbel haben eine direkte Verbindung zu den inneren Organen. »

Der Heilpraktiker und Wegbereiter für die Dornmethode, Helmut Koch, kontrolliert die Beinlängendifferenz.

Nasennebenhöhlenentzündung? Es lässt sich häufig nicht so genau erfassen. Doch eines ist sicher: Das Skelett, die Organe, die Nerven und die Psyche stehen in einem engen Zusammenhang zueinander. Bei sämtlichen Problemen mit den Gelenken, bei organischen Beschwerden oder allgemein nach einem Sturz oder nach körperlicher Belastung ist es deshalb wichtig, nicht nur in der Peripherie oder beim betreffenden Organ zu arbeiten, sondern auch an die Wirbelsäule zu denken und die Wirbel und Gelenke ins Gleichgewicht zu bringen.
Die Wirbelsäue in Harmonie bringen
Eine ganzheitliche und äusserst sanfte Therapie für die Wirbelsäule ist die Dorn-Methode. Sie wurde von Dieter Dorn, einem Landwirt aus dem Allgäu entwickelt, der seine Nachbar*innen, Kund*innen und Bekannten damit behandelte. Jede Dorn-Behandlung beginnt mit dem Ausgleich eines allfälligen Becken-Schiefstandes, weil ein gerades Becken zentral ist für eine gesunde Wirbelsäule. Die Dorntherapie konzentriert sich auf das Becken, die Gelenke und den Dornfortsatz, dem, nach hinten abstehendem Teil des Wirbels. Dorn-Therapeut*innen erkennen durch Abtasten diejenigen Wirbel, welche aufgrund der verkrampften Muskulatur in einer falschen Position blockiert sind. Durch das Lösen der Muskulatur entlang der Wirbelsäule gleiten die Wirbel in ihre angestammte Position zurück. Das geschieht unter leichtem Druck der Fachperson und rhythmischen Bewegungen der Klient*innen. Die Korrektur von Kreuz- und Steissbein erfolgt im Stehen, die der Brust- und Halswirbelsäule im Sitzen. Während der Behandlung bewegen die Klient*innen entweder die Beine, die Arme oder den Kopf. Dadurch unterstützen sie die natürlichen Bewegungen der Wirbelsäule und helfen den Wirbeln, an den richtigen Ort zu gleiten. Sind die Wirbel gerichtet, lassen die Beschwerden in der Regel rasch nach. Im Gegensatz zu anderen Therapien wie die Chiropraktik oder die Osteopathie erfor-
dert die Wirbeltherapie nach Dorn die aktive Mithilfe von Seiten der Klient*innen während der Sitzung und danach. Dabei wird nicht manipuliert und eingerenkt. Das Ausrichten der Wirbelsäule erfolgt ausschliesslich über das Lösen der Muskulatur, welche die Wirbel hält.
Am Ende der Behandlung erhalten die Klient*innen ein Merkblatt mit Selbsthilfeübungen, die sie zu Hause durchführen müssen. Die Übungen spielen eine wesentliche Rolle im Therapieerfolg, für die Stabilisierung der Wirbelsäule und die Erhaltung des Beckenstandes.
Die Dorn-Therapie ist eine Therapiemethode der Komplementärmedizin und ist nicht wissenschaftlich anerkannt. Sie eignet sich zur Behandlung von Beschwerden im Bereich der Wirbelsäule, des Nackens und der Rückenmuskulatur. Auch bei Schmerzen in einzelnen Gelenken kann mit Dorn behandelt werden. Die DornTherapeuten und -Therapeutinnen arbeiten ausschliesslich mit Gesunden, die vorübergehend Schmerzen haben. Kontraindiziert ist die Dorn-Therapie bei akuten Erkrankungen, Entzündungen und Verletzungen. Auch Bandscheibenvorfälle, ausgeprägte Osteoporose, Tumore und entzündlich-rheumatische Erkrankungen gehören in die Behandlung einer Ärztin oder eines Arztes.
In der Naturheilkunde, und auch bei der Dorn-Methode, wird der Körper in Segmente eingeteilt, die immer einen Bezug zu den Wirbeln haben. Die ersten drei Halswirbel betreffen den Kopf, der vierte betrifft den Bereich des Halses und vorne das Schlüsselbein, und die Halswirbel fünf bis sieben die Arme, Hände und Finger. Gut zu beobachten ist die Einteilung in Segmente beim Ischias Schmerz. Er strahlt oft über das Gesäss in den Oberschenkel bis zur Wade. Die Beine schmerzen, obwohl sie vollkommen gesund sind, weil sie sich in der

Die Wirbelsäule, das Zentrum unseres Körpers
Dieter Dorn, der Begründer der Dorn-Methode lebte von 1938 bis 2011 im Allgäu. Er arbeitete in einem Sägewerk und einem Landwirtschaftsbetrieb. 1973 wandte er sich mit akuten Schmerzen im Rücken an einen Bauern aus dem Nachbarort. Der «Einrenker» behandelte auch Dieter Dorn erfolgreich. Das schnelle Verschwinden seiner Rückenschmerzen machte Dorn neugierig. Er entwickelte die Methode des Rückenheilers, wie er im Dorf genannt wurde, weiter und behandelte nach und nach erfolgreich seine Familie, Nachbar*innen und Bekannte.
Die Ursache für viele Schmerzen im Bewegungsapparat fand Dieter Dorn im Bereich der Wirbelsäule. Er behandelte Menschen mit entsprechenden Beschwerden und gab ihnen zusätzlich eine Anleitung zur Selbsthilfe in die Hand. Heute ist die Wirbelsäulentherapie nach Dorn längst nicht mehr nur im Allgäu bekannt, sondern wird auch in der Schweiz von vielen Therapeut*innen erfolgreich angewendet.
Zone des verschobenen vierten Lendenwirbels befinden, der die typischen Ischias Schmerzen hervorruft. Auch bei Magenbeschwerden, die sich selbst mithilfe einer Ernährungsumstellung nicht wesentlich verändern, darf man an die Brustwirbel sechs und sieben denken. Sind diese leicht verschoben, hat das Auswirkungen auf die Energieversorgung und Durchblutung des Magens.
Die Liste auf Seite 16 verdeutlicht die möglichen Zusammenhänge zwischen Wirbeln und Organen. Sie ist nicht vollständig und kann je nach Quelle leicht variieren. Besprechen Sie mit Ihrer behandelnden Fachperson die denkbaren Verknüpfungen. Das regelmässige Ausrichten der Wirbelsäule kann die Gesamtgesundheit stärken und den Körper stabilisieren, weil alles miteinander zusammenhängt und weil der Mensch nur in seiner Ganzheit einen Zugang zu seinen Selbstheilungskräften hat.
Nahrung für die Wirbelsäule
Bandscheiben und Gelenkknorpel sind wie Schwämme, die sich mit Flüssigkeit aufsaugen müssen, um die Aufgabe des Abdämpfens von Schlägen zu verrichten. Deshalb ist es wichtig, täglich mindestens zwei Liter Wasser oder ungesüssten Tee zu trinken. Besonders dann, wenn Sie an Rückenschmerzen leiden oder in einer Dorn-Behandlung sind. Zudem sind die Knorpelstrukturen zwischen den Gelenken und die Bandscheiben anfällig auf ein Zuviel an Säure im Körper. Mineralstoffreiche, pflanzliche Nahrung ist zu bevorzugen. Essen Sie täglich fünf Portionen Obst und Gemüse und reduzieren Sie zugunsten dieser Frischkost Fleisch, Getreide und Milchprodukte. Alles, was die Wirbelsäule nährt und stärkt, ist ein wichtiger Beitrag für die eigene Gesundheit. Oft sind es nicht einmal die kräftigenden Rückenübungen, sondern ganz im Gegenteil, die Entspannungsübungen, das flach-auf-dem-hartenBoden-liegen und die weichen Dehn- und Bewegungsformen, die im Fluss des Atems ohne Kraft und Drill ausgeführt werden, welche der Wirbelsäule und den Rückenmuskeln guttun. Qi Gong zum Beispiel, Yoga, Lu Jong oder Tai Chi. Egal was Sie tun: Machen Sie es aus Liebe zu sich selbst, weil Sie ehrlich und aufrichtig gesund sein wollen. Ebenfalls eine wichtige Affirmation und zentral für jeden Therapieerfolg.
Die Gartenbauschule bietet folgende Lehrstellen an:
Die Gartenbauschule bietet folgende Lehrstellen an:
– Gärtner/-in EFZ Garten- und Landschaftsbau
– Gärtner/-in EFZ Zierpflanzen
– Gärtner/-in EFZ Garten- und Landschaftsbau
– Gärtner/-in EFZ Stauden
– Gärtner/-in EFZ Zierpflanzen
– Gärtner/-in EBA Garten- und Landschaftsbau
– Gärtner/-in EFZ Stauden
– Gärtner/-in EBA Pflanzenproduktion
– Gärtner/-in EBA Garten- und Landschaftsbau
– Florist/-in EFZ
– Gärtner/-in EBA Pflanzenproduktion
– Vorlehre Garten und Bau
– Florist/-in EFZ
– Vorlehre Garten und Bau
Nähere Angaben finden Sie
Nähere Angaben finden Sie
unter: www.oeschberg.ch
unter: www.oeschberg.ch
Wir freuen uns auf Sie!

Wir freuen uns auf Sie!




Für Kinder ist die Vorweihnachtszeit etwas ganz Besonderes. Das gemeinsame Güetzibacken ist in vielen Familien ein festes Ritual. Mit guter Vorbereitung und angepassten Erwartungen wird diese Tradition für Gross und Klein zu einem schönen Erlebnis.
Therese Krähenbühl
Die Tage werden kürzer und Weihnachten rückt näher. Es ist die Zeit, in der man es sich daheim gemütlich macht, Tee trinkt und Güetzi bäckt. Gerade an stürmischen, verregneten oder verschneiten Tagen, wenn man nicht draussen spielen kann, ist es herausfordernd Kinder sinnvoll zu beschäftigen. Das gemeinsame Backen ist eine willkommene Abwechslung. Gerade mit Kindern braucht es aber gute Vorbereitung, damit der Backnachmittag harmonisch verläuft und nicht im Chaos endet.
Niemand zu klein, Bäcker*in zu sein?
Bereits sehr kleine Kinder zeigen Interesse an den Tätigkeiten der Erwachsenen und freuen sich, wenn sie daran teilhaben können. Trotzdem ist das Ausstechen von Teig und das Verzieren der Backwaren für ganz kleine Kinder noch eine Überforderung. Daher gilt es, einen Mittelweg einzuschlagen und zu akzeptieren, dass ein gut einjähriges Kind nicht viel mehr tun wird, als seine Fingerchen in den Teig zu drücken und allenfalls noch etwas davon zu naschen. Aber das ist völlig in Ordnung. Denn so hat es trotzdem die Gelegenheit an den Abläufen teilzunehmen und etwas zu lernen. Ein Jahr später wird es unter Umständen schon mit viel Eifer seine eigenen Güetzi ausstechen.
Zuckermenge dosieren
Grundsätzlich gilt es, die Erwartungen und auch den Schwierigkeitsgrad dem Alter der Kinder anzupassen. Teige, die zu sehr kleben oder mürbe und zerbrechlich sind, und bereits Erwachsene an ihre Grenzen bringen, sind nichts für kleine Kinderhände. Da kann es eine schöne Alternative sein, die Güetzi bereits vorher zu backen und dann nur noch mit den Kindern zu verzieren. Aber auch dabei sollte keine Perfektion verlangt werden. Kinder werden den Zuckerguss von den Fingern lecken, von der Deko probieren und allenthalben das Backen eher als Experimentierfeld sehen.

Stempel zum Prägen von Güetzi sind im Moment voll im Trend und lassen sich gut in Mailänderli-Teig anwenden.
Zutaten: 200 g weiche Butter, 250 g Zucker, 4 Eier, 1 Prise Salz, 1 Zitrone, Zitronenschale, 1 TL Vanillezucker und 500 g Mehl.
Zubereitung: Die Butter mit dem Zucker, den Eiern, dem Salz, der Zitrone und dem Vanillezucker mit dem Handrührwerk zu einem luftigen Teig verrühren, danach unter weiterem Rühren das Mehl dazu sieben, bis sich ein fester Teig gebildet hat. Diesen noch etwas von Hand zusammenfügen und zugedeckt mindestens eine Stunde im Kühlschrank stehen lassen.
Den Backofen auf 180 Grad vorheizen und derweilen den Teig knapp 1 cm dick ausrollen und die Mailänderli zuerst mit einem Stempel prägen und danach ausstechen. Die Güetzi auf einem Blech verteilen und vor dem Backen sorgfältig mit Eigelb bestreichen. Die Backzeit beträgt ungefähr 12 Minuten. Es ist aber wichtig, dass man die Güetzi immer im Auge behält, damit sie perfekt golden werden. tku

Lebkuchen sind die Klassiker unter den Weihnachtsgüetzi. Der Teig dafür muss nicht unbedingt gekauft, sondern kann auch selbst hergestellt werden. Vorgehen: 500 G Mehl, 2 Esslöffel Lebkuchengewürz, 85 g Zucker, 250 g Honig, 1 dl Milch und 1 Esslöffel Natron gut zusammen verkneten. Den Teig etwa eine halbe Stunde im Kühlschrank ruhen lassen, danach 5 mm dick auswallen und die Güetzi ausstechen. Die Lebkuchen 12 Minuten bei 180 Grad in der Ofenmitte backen, direkt danach mit Kaffeerahm bestreichen und auskühlen lassen. Im Anschluss können die Lebkuchen mit Zuckerguss und Sträuseln verziert werden. tku
Für alle, die eigentlich gar keine Zeit zum Backen haben, sind diese Mandelgüetzi, die in weniger als einer halben Stunde hergestellt werden können, perfekt. Zusätzlich sind die Güetzi mehlfrei, was sie für Menschen mit einer Glutenunverträglichkeit bekömmlich macht.
Zutaten für ca. 20 Stück: 200 g gemahlene Mandeln, 150 g Zucker, 2 Eiweiss, 1 TL Vanilleextraxt oder 1 Pack Vanillezucker, für die Erwachsenen-Variante Amaretto (diesen bei den Kindern bitte weglassen), Puderzucker
Zubereitung: Die Mandeln und 2 EL Wasser oder optional für die Erwachsenen-Variante Amaretto vermischen. Das Eiweiss gut mit dem Zucker, dem Vanillezucker und den Mandeln verrühren. Mit zwei Löffeln Kugeln formen und diese im auf 180 Grad vorgeheizten Ofen 12 Minuten backen. Daran müssen Sie sich genau halten, da die Kekse so die perfekte Konsistenz (innen weich, aussen schön knusprig) bekommen. Zum Dekorieren werden 10 EL Puderzucker mit 3 EL Amaretto bzw. Wasser vermischt. Diesen Zuckerguss ganz einfach in einen Plastiksack füllen, diesen an einer Ecke aufschneiden und den Zuckerguss so über die Güetzi verteilen und das Ganze zum Schluss nach Belieben dekorieren. tku
Hierbei kommt bei Erwachsenen oft auch die Sorge auf, dass der viele Zucker den Kindern schaden könnte. Dazu gibt es Alternativen. Wer es süss mag, aber auf weissen Zucker verzichten möchte, backt einfach den Klassiker Lebkuchen, der mit Honig gesüsst wird. Alternativ finden sich in den Weiten des Internets feine Rezepte für das Backen ohne Zucker. Güetziteig kann auch mit Datteln oder reifen Bananen gesüsst werden. Oft merken Kinder während des Naschens aber ganz von selbst, dass ihnen der Zucker zu viel wird und hören wieder damit auf.
Kugeln, prägen, plattdrücken
Wenn ein Kind etwas grösser ist und allenfalls auch bereits einige Erfahrungen in der Küche gesammelt hat, wird es ihm Freude machen, bereits bei der Herstellung des Teigs – besonders beim Kneten – behilflich zu sein. Es bieten sich nicht nur Teige an, die ausgestochen werden müssen, sondern auch solche, die zum Beispiel mit den Fingern zu einer Kugel geformt und etwas plattgedrückt werden können, wie das bei den Mandelgüetzi (siehe Kasten) der Fall ist. Teig kann nicht nur ausgestochen und mit Zuckerguss verziert, sondern auch ganz einfach mit einem Prägestempel verschönert werden. Mittlerweile findet man diese in allen gut sortierten Geschäften für Backzubehör. Das Prägen von Mustern in Teig gelingt schon sehr kleinen

Kindern. Ein klassischer Mailänderliteig, der zur Not auch mal im Grossverteiler gekauft werden darf, eignet sich besonders gut dafür.
Die Aufgaben aufteilen
Da das Backen auch immer mit Hitze und dem Einhalten von Zeiten einhergeht, damit die Güetzi auch ja nicht verbrennen, sollte das Ganze idealerweise von zwei Erwachsenen begleitet werden. Ein heisser Ofen ist und bleibt eine Gefahrenquelle für Kinder. Da Weihnachtsgüetzi oft nur eine kurze Backzeit haben, gleichzeitig ja aber auch das Kind oder die Kinder betreut werden sollten, ist es sinnvoll, sich diese Aufgaben zu teilen.
Gute Stimmung statt Perfektion
Schlussendlich geht es beim gemeinsamen Backen um das Erlebnis. Kinder und Erwachsene sollen sich auf Weihnachten einstimmen, das gemütliche Beisammensein und den Duft von frischem Gebäck geniessen können. Anspruch auf Perfektion ist hier fehl am Platz. Auch Zeitdruck sollte man nicht haben. Und wenn das Backen nicht funktioniert hat, wie erwartet, wird der Teig einfach im Kühlschrank kaltgestellt oder eingefroren und in einem ungestörten Moment mit Kerzenlicht und einer Tasse Punsch gebacken, wenn das Kind schläft. Am nächsten Morgen wird es sich dann umso mehr über die süsse Überraschung freuen.




VERDAUUNG benötigt Wärme
Calcium trägt zur normalen Funktion von Verdauungsenzymen bei.
Tibetische Rezepturen aus der Schweiz. Natürlich!


Dieses Guetzli bleibt, was es immer war: spitzbübisch. Und es schmeckt nicht nur zu Weihnachten. Wer spitzfindig ist und gut organisiert, kann mit dem Backen niemals früh genug beginnen. Auch bei diesen Exemplaren. Die Bürschchen aus glutenfreiem Buchweizenmehl sind fein im Geschmack und halten brav. Doch wehe, wenn sie einmal losgelassen. Da hilft nur: schnell den Deckel wieder drauf!
Ergibt 2 Bleche oder ca. 35 Stück
250 g Butter, weich
125 g Puderzucker
1 Prise Salz
1 Eiweiss
200 g Biofarm Buchweizenmehl hell
150 g Biofarm Dinkelhalbweissmehl
Ca. 200 g Cassis-Gelee
Wenig Puderzucker zum Bestäuben
Spitzbuben mit Buchweizenmehl hell
1. Butter, Puderzucker und Salz in einer Schüssel schaumig rühren.
2. Eiweiss verklopfen, darunterrühren. Buchweizen- und Dinkelmehl beigeben, zu einem Teig zusammenfügen, etwas flach drücken, zugedeckt mind. 2 Std. kühl stellen.
3. Ofen auf 200 Grad vorheizen.
4. Auf der Arbeitsfläche etwas Mehl verteilen und den Teig ca. 3 mm dick auswallen. Rondellen von 3–4 cm Durchmesser ausstechen. Bei der Hälfte der Guetzli, die als Deckel bestimmt sind, mit einem kleinen Förmchen die Mitte ausstechen.
5. Guetzli auf mit Backpapier belegte Bleche legen, ca. 15 Min. kühl stellen.
6. Backen: je ca. 6 Min. in der Ofenmitte. Herausnehmen, Guetzli auf einem Gitter auskühlen.
7. Cassis-Gelee in einer kleinen Pfanne etwas erwärmen, glattrühren und auf die flache Seite der Guetzli-Böden verteilen.
8. Deckel mit Puderzucker bestäuben und auf die Guetzli-Böden setzen.

Wenn sich zwei starke Partner zusammentun, dann können sie vieles erreichen. Aus diesem Grund arbeiten «natürlich» und der Dachverband Komplementärmedizin Dakomed künftig enger zusammen. Ziel ist, die Bevölkerung noch besser über naturheilkundliche Themen zu informieren – und der Komplementärmedizin mehr Gewicht zu verleihen. Naturheilkunde ist beliebt. Bei allerlei körperlichen und seelischen Beschwerden nehmen Schweizerinnen und Schweizer gerne natürliche Heilmittel oder komplementärmedizinische Therapien in Anspruch. Dies nicht zuletzt dank «natürlich», das seit 41 Jahren konsequent über die vielen Möglichkeiten und Wirkungen der Naturheilkunde berichtet.
Trotzdem: in der öffentlichen und vor allem der politischen Wahrnehmung steht die Naturheilkunde nach wie vor im Schatten der finanzmächtigen Pharmaindustrie und der Schulmedizin.
Hier kommt der Dachverband Komplementärmedizin Dakomed ins Spiel. Gegründet wurde er 2009 kurz nach der Annahme des Gegenvorschlags zur Volksinitiative «Ja zur Komplementärmedizin», dank dem Homöopathie, Traditionelle Chinesische Medizin (TCM), anthroposophische Medizin, Neuraltherapie und Phytotherapie in die Grundversicherung der Krankenkassen aufgenommen werden mussten. Aufgabe des Dakomed ist seither, darüber zu wachen, dass die Kernforderungen der Abstimmung unverwässert umgesetzt werden.
Gegengewicht zur Pharma-Lobby
Doch allein damit gibt sich der Dakomed nicht zufrieden. Erfolgreich hat er sich seit seiner Gründung für die Professionalisierung der Ausbildung naturheilkundlich ausgerichteter Therapeutinnen und Therapeuten bis hin zum eidgenössischen Diplom und die

vereinfachte Zulassung für pflanzliche und komplementärmedizinische Arzneimittel eingesetzt. Mittlerweile vereint der Dakomed über 20 Verbände und Organisationen und vertritt dort als Konterpart zur Pharma-Lobby deren Anliegen im Bundeshaus, initiiert parlamentarische Vorstösse, reicht Stellungnahmen ein und führt zudem die Geschäftsstelle der parlamentarischen Gruppe Komplementärmedizin.
Gemeinsam für die Naturheilkunde
Wenn zwei dasselbe Ziel haben, dann lohnt es sich, gemeinsam darauf hinzuarbeiten. Im Wissen darum, wie wichtig und heilsam die meist nebenwirkungsfreie Komplementärmedizin ist, arbeiten «natürlich» und Dakomed enger zusammen, ohne dabei ihre Eigenständigkeit zu verlieren, denn: die vielen Menschen, die ihrer Gesundheit Sorge tragen und der Naturheilkunde vertrauen, haben ein Recht darauf, auch in Zukunft gut informiert und im Bundeshaus vertreten zu sein. (kel)
Millefolia-Bulletin im «natürlich»
Liebe Leserin, lieber Leser
Eigentlich hätte das aktuelle «Millefolia-Bulletin» schon in der letzten Ausgabe beigelegt sein müssen – aber uns ist ein Fehler passiert. Nun finden Sie das «Millefolia-Bulletin» in dieser Ausgabe.
Mit dem «Millefolia-Bulletin» informiert der Dakomed zwei Mal jährlich über seine politische Arbeit, angereichert mit aktuellen Nachrichten aus der Welt der Komplementärmedizin. Auf der zum Bulletin gehörenden Website «millefolia.ch» finden Sie zudem täglich eine breite Palette von Artikeln zu und über die Naturheilkunde. Für seine politische Arbeit ist der Dakomed auf Ihre Unterstützung angewiesen.
Haben Sie schon mal ein Gefäss aus Ton auf einer Drehscheibe geformt? Was bei Profis so überaus elegant aussieht, ist in Tat und Wahrheit eine Achtsamkeitsschule sondergleichen. Ist der Ton auch nur ein bisschen ausserhalb der Mitte, fliegt die feuchte Erde in hohem Bogen durch die Luft oder nimmt, gut angeklebt auf der Scheibe, schlingernde Formen an. Jeder Handgriff erfordert ein Maximum an Präsenz und der kleinste Fehler bringt den Ton sofort aus der Balance. Zentrierung erfahren wir bei vielen Präzisionsarbeiten und Tätigkeiten, die absolute Konzentration erfordern. Sei es in der Meditation, beim Tanzen oder im Yoga. Damit es gelingt, muss der Fokus im Hier und Jetzt sein. Oft halten wir uns dabei aufgerichtet. Beim Meditieren ist der Rücken gerade und der Kopf leicht gesenkt. Beim Tanzen ist der Brustkorb geöffnet und die Wirbelsäule lang gestreckt. Ebenso beim Yoga, wenn die Balance auf einem Fuss stehend gehalten werden muss.
Im Zentrum unseres Körpers und somit auch im Zentrum unseres Lebens steht immer die Wirbelsäule. Wie bei einem Baum, der über den Stamm, die Baumkrone und die Wurzeln zwischen Himmel und Erde verbunden ist, so sind wir Menschen über die Wirbelsäule mit den Füssen und dem Scheitel verbunden. Wir stehen aufrecht mit den Füssen auf dem Boden und spüren über unserem Kopf die unendliche Weite des Himmels. Mal angenommen, wir sind uns unserer Wirbelsäule permanent bewusst, indem wir sie uns vorstellen als stützende Haltgeberin, als Verbindungslinie zwischen Mutter Erde und Vater Sonne, sowie als energetischen Kanal zwischen Kopf und Füssen. Stellen Sie sich vor, jeder Mensch würde sich auf diese Weise als Lebewesen wahrnehmen, das mit sich selbst verbunden ist und

gleichzeitig mit den übergeordneten Kräften der Natur und der Elemente. Es wäre eine Präsenz, die über das Körperliche hinausgeht und in vieler Hinsicht hilfreich, heilsam und tröstlich wäre. Fernab von Religion und Esoterik, sondern allein dank dem Verständnis und dem Bewusstsein, dass die Wirbelsäule eine aufrechte Achse ist, durch die unsere Lebensader fliesst.
Je näher die Aufmerksamkeit bei der Wirbelsäule ist, desto ruhiger ist der Geist. Was wir in Achtsamkeit tun, führen wir in der Regel langsam und ruhig aus. Je weiter ein Körperteil von der Wirbelsäule entfernt ist, desto grössere Bewegungsradien sind möglich. Denken wir nur an die Hände und Füsse, die Beine und Arme. Sie sind verantwortlich für alle Bewegungsaktivitäten des Körpers. Solange wir über die Wirbelsäule mit den Händen und Füssen in Verbindung sind und diese achtsam wahrnehmen, kommen alle Aktivitäten irgendwo aus dem Zentrum unserer eigenen Kraft. Verlieren wir hingegen die Verbindung zur Mitte, ist die Energie mehr in den Händen, die tun und den Füssen, die herumrennen. So geht es uns wie dem Klumpen Ton auf der Drehscheibe eines Anfängers. Es schleudert uns herum, wir sind im Aussen, zu schnell unterwegs, atemlos und getrieben. Machen Sie die Wirbelsäule zum stillen Zentrum Ihres täglichen Tuns. Drehen Sie sich um die eigene Achse wie eine grazile Tänzerin – konzentriert und doch beweglich.
Doch was, wenn uns der Alltag zu erdrücken droht? Wenn die Anerkennung für die täglichen Tätigkeiten fehlt und das schale Gefühl aufkommt, sehr allein zu sein und alles selbst tragen zu müssen? Nicht nur die Kinder, auch die Erwachsenen benötigen Lob und Anerkennung. Leider ist es oft so, dass im Alltag genau
diese Bestätigung fehlt und latent das Gefühl da ist, nicht zu genügen. Um gesehen und anerkennt zu werden, verausgaben sich viele Menschen im Beruf oder im Privatleben bis zur Erschöpfung, was jedoch nicht die Lösung ist. Der Mangel an Unterstützung, oder zumindest das Gefühl der fehlenden Hilfe, auf einer tiefen seelischen Ebene kann sich in Rückenproblemen zeigen. Der Mensch in seiner Emotionalität und Weichheit braucht andere Menschen um zu leben. Wir helfen einander, schwere Lasten zu tragen, uns geborgen zu fühlen und Ruhe zu finden. Menschen benötigen Zuspruch, Lob und Anerkennung um die Unterstützung zu bekommen, die sie sich wünschen. Fangen Sie an, Ihren Mitmenschen zuzuhören. Interessieren Sie sich ehrlich und aufrichtig für die Menschen und ihre Geschichten in Ihrer Umgebung. Machen Sie ernst gemeinte Komplimente und drücken Sie Ihre Bewunderung aus für eine geleistete Arbeit. Eine solche Haltung hilft allen – den Personen, die das Lob empfangen und jenen, die es aussenden.
Eine unterstützende Haltung dem Umfeld gegenüber schafft eine gute Atmosphäre und kitzelt ein enorm wichtiges Grundgefühl wach – das Vertrauen. Nichts gibt so viel Zentriertheit und Mut wie die Gewissheit, dass das Leben hinter Ihnen steht. Sicherheit können wir nicht im Aussen finden. Sicherheit, das Gefühl, in Sicherheit zu sein, hat nichts zu tun mit finanzieller Sicherheit. Viele materielle Dinge, durch die wir uns sicher und geschützt fühlen, können wir jederzeit verlieren. Was wir hingegen im innersten stärken müssen, ist das Vertrauen und das Gefühl, in Sicherheit zu sein. Das kann und muss jeder Mensch in sich selbst generieren. Mit Hilfe der Verbindung zu sich selbst, der Verbindung zu den übergeordneten Elementen und der Verbindung zum Leben. Treffen wir uns dort, wo die Zeit stillsteht! Treffen wir uns dort, wo Aufrichtigkeit, Sicherheit und Geborgenheit herrscht! Jeder und Jede in der Mitte der eigenen Lebens-Dreh-Scheibe, der Körperachse, der Wirbelsäule.
Sabine Hurni arbeitet als Naturheilpraktikerin und Lebensberaterin in Baden, wo sie auch Ayurveda Kochkurse, Lu Jong- und Meditationskurse anbietet.

Ich bin 64 Jahre alt. Aufgrund von Röntgenbildern und MRI wurde Ende März 2022 bei mir Osteoporose diagnostiziert. Ich bekam kurz darauf meine erste Prolia-Spritze, im November ist die zweite fällig. Ich habe inzwischen viel Negatives über diese Medikamente gelesen und frage mich, ob ich überhaupt weiterfahren soll. Ist es möglich, allein mit der Ernährung eine Osteoporose zu behandeln? Wie ist Ihre Meinung dazu?
S. B., Bern
Das ist keine einfache Entscheidung. Risiko versus Nutzen von Prolia ist tatsächlich sehr umstritten. Alle Medikamente abzusetzen und ausschliesslich auf die Ernährung setzen, scheint mir jedoch auch ein ziemlich radikaler Schritt. Den müssen Sie zu 200 Prozent wollen, mit allen Konsequenzen – von irritierten Schulmediziner*innen, die sämtliche Verantwortung von sich weisen bis hin zur tiefen Auseinandersetzung mit sich selbst und den inneren Themen. Oder anders gesagt. Sie sollten nicht aus Angst vor den Nebenwirkungen auf ein Medikament verzichten, sondern aus der tiefen Überzeugung heraus, dass Ihr Körper das auf natürliche Weise schafft.
Eine Überlegung wäre die Fristverlängerung. Besprechen Sie mit Ihrer Hausärztin oder mit einer alternativ arbeitenden Fachperson, zum Beispiel aus dem Bereich Anthroposophie, wie lange sie zuwarten können mit der zweiten Spritze, wenn Sie in den nächsten zwei oder drei Jahren sich sehr intensiv mit der Ernährung und ihrem inneren Halt befassen. Die Ärzt*innen

müssen Sie aufklären über das Worst-Case-Szenario und das Best-Case-Szenario. Die Wahl liegt bei Ihnen. Es ist Ihr Körper und Ihre Entscheidung. Eine gute Ärztin wird sie immer begleiten, auch wenn sie sich für einen anderen Weg entscheiden, als sie empfohlen hat.
Wir sind hier schon mitten im Thema der Standhaftigkeit. Das Hintergrundthema des Knochenschwunds –auf seinen eigenen Beinen stehen, keine Rolle spielen, sondern sein echtes inneres Wesen leben, das nicht immer allen gefällt. Denken Sie zurück. Was waren Ihre Träume, als Sie 16 Jahre alt waren? Dieses Wesen, der jungen Frau, die das Leben vor sich hat, dürfen wir alle bis ins hohe Alter immer wieder reaktivieren.
Nun aber zur Ernährung. Essen Sie warm, drei warme Mahlzeiten pro Tag. Nehmen Sie ein natürliches Kalziumpräparat ein, das auch Vitamin K2 enthält. Achten Sie auf den Säure-Basen-Haushalt. Zuviel Lebensmittel, die unter Bildung von Säuren abgebaut werden, sorgen für noch mehr Entkalkung des Knochens. Also Fleisch, Fisch, Käse reduzieren und nur zusammen mit sehr viel Gemüse essen. 20 Prozent Fleisch, 80 Prozent Gemüse. Machen Sie immer wieder Basentage, an denen Sie ausschliesslich Gemüse, Obst und Früchte zu sich nehmen. Und noch ein Ayurveda-Tipp: Ölen Sie sich zweimal die Woche von Kopf bis Fuss mit Sesamöl ein. Vor dem Duschen das Öl wärmen, auf die trockene Haut massieren, etwas einwirken lassen und dann duschen. Das Öl nährt die Knochen sehr effizient.
Wenn Sie sich mit der Basenküche auseinandersetzen und gleichzeitig warm essen, saftig und sämig. Und auch darauf achten, dass Sie nicht zu viel Trockenes wie Kräcker, Brot, Reiswaffeln, Trockenobst usw. konsumieren, dann sind sie schon mal auf dem guten Weg. Sie dürfen sich aber sehr gerne bei mir melden für eine Beratung. Das würde ich sehr gerne machen. Egal ob mit oder ohne medikamentöse Behandlung.
LEITUNGSWASSER FILTERN?
Wie stehen Sie zu gefiltertem Leitungswasser? Ich trinke Leitungswasser und lasse es für den Tee durch den Brittafilter rieseln. Zwecks Entkalkung. Kürzlich kaufte ich einen neuen Filter, der das Leitungswasser von Schadstoffen befreien und basisch «machen» soll. So ganz überzeugt bin ich aber nicht. Am liebsten hätte ich eine eigene Quelle!
D. R., Winterthur
Ja diese Wasserfilter … Ich finde es okay, wenn man gefiltertes Wasser zum Kaffeekochen benutzt, um die Maschine oder den Wasserkocher vor Kalk zu schützen. Aber zum Trinken? Nein. Meine Eltern haben in ihrem Haus eine fix installierte Entkalkungsanlage. Das Wasser schmeckt scheusslich. Wie Seife. Da vergeht einem die Lust am Wassertrinken.
Das Schweizer Wasser ist eines der sichersten und saubersten Lebensmittel. Und ja, es sind Schadstoffe, Hormone und Düngemittel drin, die sich nicht herausfiltern lassen. Aber überlegen Sie sich mal, wie ungesund sich viele Leute ernähren. Wie viele Medikamente geschluckt und wie viele Genussmittel konsumiert werden. Wir können im Leben nicht alles als Bedrohung ansehen, was nicht rein und klar ist wie eine Wasserquelle. Wir können schlicht nicht alle Schadstoffe aus dem Leben verbannen. Es bleibt uns oft nichts anderes übrig als dem System Körper zu vertrauen, dass er klarkommt und robust auf die äusseren Umweltfaktoren reagiert.
Mit einer gesunden, biologischen, pflanzenreichen Ernährung und einer ausreichenden Trinkmenge unterstützen Sie den Körper optimal dabei. Je natürlicher und ursprünglicher ein Lebensmittel ist, desto mehr Schutzstoffe liefert es unserem Körper. So kräftigen Sie den Körper, um mit Umweltfaktoren zurecht zu kommen. Trinken Sie das Wasser nicht direkt ab Leitung, sondern füllen Sie es zuerst in einen Krug aus Glas oder Keramik. So kann sich das Wasser beruhigen und schmeckt allein dadurch besser als direkt aus der Leitung. Sie können Ihr Leitungswasser auch aufpeppen, indem Sie ein paar Pfefferminzblättchen hineinlegen, einen Schnitz Zitrone oder ein Stück Gurke. Alles basische Bestandteile. Wenn Sie sich nach Quellwasser sehnen, könnten Sie einen Tropfen der Bachblütenmischung 27, Rock Water in den Krug geben. Das vermittelt dem Wasser die Energie der Quelle, und hilft generell, mehr im freudvollen Lebensfluss zu sein.

Gesundheitstipp
Lass dich von deiner Durchblutung mitreissen
Durchblutung ist mehr als nur Kreislaufsache. Vom Fluss des Lebens ist der ganze Körper abhängig. Bereits die jahrhundertealte Tibetische Medizin hat dies erkannt und sogar eigene Kräuterrezepturen dafür entwickelt.
Die Tibeter nutzen seit jeher bitterherbe, naturbelassene Kräuter, Gewürze und Mineralien für ihre Durchblutungs-Arzneien. Das Arzneimittel PADMA 28N konzentriert das Wissen der Tibetischen Medizin in einer Kapsel und vereint 19 Kräuter und Gewürze, natürlichen Campher und Calciumsulfat. PADMA 28N kann bei Durchblutungsstörungen mit Symptomen wie eingeschlafenen Händen und Füssen oder Wadenkrämpfen helfen.
Dies ist ein zugelassenes Arzneimittel. Lesen Sie die Packungsbeilage. PADMA AG www.padma.ch


VERTRAUEN
Ein Patient verstirbt plötzlich. Als die Angehörigen die Nachricht über den Tod erhalten, sind sie geschockt und fragen sich, ob etwas falsch gelaufen ist. Dafür beantragen sie Akteneinsicht. Das Spital ist einverstanden, aber die kantonale Gesundheitsdirektion, die bei Todesfällen ebenfalls über die Aktenfreigabe zustimmen muss, verweigert die Herausgabe – was Familie erst recht misstrauisch macht. Was war geschehen und was ist in solchen Situationen zu tun?
Leider war es dem Behandlungsteam im Spital nicht gelungen, der Familie den Ernst der Situation ihres Angehörigen zu vermitteln. Deren Unverständnis und ihr Bedürfnis, die Behandlung extern prüfen zu lassen, sind somit nachvollziehbar. Medizinisch lag aber kein Fehler vor. Warum wurde das Dossier dann nicht gleich herausgegeben? Das Bundesgericht urteilte, dass der Persönlichkeitsschutz auch nach dem Tod gelte. Angehörige müssen einen Herausgabewunsch demnach begründen, etwa mit einem Verdacht auf Verletzung der ärztlichen Sorgfaltspflicht. Das Problem: Erst der Blick in die Akten ermöglicht, einen solchen Verdacht begründet zu erheben (oder zu entkräften).
Der Persönlichkeitsschutz ist ein hohes Gut. Jedoch sollte auch das Misstrauen, das eine Nicht-Herausgabe bei den Angehörigen schürt, in die Abwägung der Gesundheitsdirektionen einfliessen. Durch Transparenz gewinnen alle Akteur*innen.
Nicole Rapin, Patientenberaterin SPO
Mehr zum Thema Patient*innenrecht:
Schweizerische Stiftung SPO Patientenschutz, www.spo.ch
Telefonische Beratung via Hotline 0900 567 047, Fr. 2.90/Min.
Im Rahmen der SPO-Mitgliedschaft erhalten Sie diese Beratung unentgeltlich (044 252 54 22).
Mein Mann ist 67 Jahre alt und hat nun zum dritten Mal innerhalb von 5 Jahren einen Nierenstein. Die Ärzt*innen raten als Vorbeugung genügend zu trinken. Was kann man sonst noch präventiv und akut alles tun?
A. B., Neuhausen
In den meisten Fällen handelt es sich bei den Steinen um Calziumoxalatsteine. Oft wird geraten, auf zu viel Oxalsäure in der Nahrung zu verzichten. Doch das ist schwierig, weil in fast allen Gemüsesorten Oxalsäure enthalten ist und der Verzicht auf Gemüse schlussendlich nicht gesundheitsförderlich sein kann. Ich würde aber darauf achten, dass Sie und Ihr Mann beim Kochen den Spinat blanchieren und Rhabarber nur in deren Saison und auch dann nicht in rauen Mengen verzehren. Immer gut schälen und kochen. Auch Tomaten enthalten Oxalsäure. Diese in der Sommerzeit geniessen und im Winter die Finger von rohen Tomaten lassen. Sie schmecken ohnehin nach nichts. Und generell beim Kochen darauf achten, dass Sie dem Körper dreimal täglich über die Nahrung Wärme zuführen. Wärme ist für die Nieren wichtig. Warme Getränke, warmes Essen, warme Füsse, einen warmen Unterrücken und – viel Herzenswärme. Die Niere ist ein Beziehungsorgan. Was die Trinkmenge betrifft so gilt: 3 Deziliter pro 10 Kilogramm Körpergewicht. Mit 90 Kilo müsste ihr Mann also 2,7 Liter Wasser trinken. Das ist viel. Man darf Suppen, Getränke und saftige Früchte mitzählen und kommt am Schluss vielleicht noch auf 2 Liter Wasser oder ungesüssten Tee. Was ebenfalls hilfreich ist, sind Fussbäder. Ein Fussbad stärkt die Nierenenergie sehr effizient. Das muss nicht täglich sein, aber vielleicht einmal die Woche. Fussbäder gehen leider oft vergessen im Alltag, dabei ist das etwas vom entspannendsten und wohltuendsten, das man seinem Körper schenken kann.
Auf der Ebene der Kräuter ist es die Brennnessel, die Birkenblätter und der Schachtelhalm, die dabei helfen, die Nieren zu durchspülen. Auch die Goldrute ist ein wertvolles Heilmittel für die Nieren, weil sie gleichzeitig auch entgiftend wirkt. Lassen Sie sich doch von den Fachleuten in der Drogerie eine Teemischung zusammenstellen, die gut auf die Thematik ihres Mannes passt.
Haben Sie Fragen?
Sabine Hurni, Drogistin, Naturheilpraktikerin und AyurvedaExpertin, beantwortet Ihre Fragen zu Gesundheits- und Ernährungsthemen persönlich und ganzheitlich: s.hurni@weberverlag.ch

Ich möchte mir an Weihnachten einen Wunsch erfüllen und meinen Liebsten mit einer erotischen Verführung überraschen. Quasi ein Geschenk für uns beide, ich freue mich tierisch darauf! Neben dem sexuellen Alltag brauchen wir eben manchmal etwas Besonderes – und was eignet sich besser dafür als das Fest der Liebe! Wann sonst haben wir einfach einmal Zeit und keine störenden Anrufe oder Termine! Zu einem erotischen Geschenk gehören meiner Erfahrung nach drei Elemente: Spiel, Hingabe und Fülle.
Spiel: Wir sind viel zu oft ernst und fixiert im Sex! Eine Rolle zu spielen, entlastet vom Zielgeraden-Sex und setzt ungeahnte Freuden frei.
Hingabe: Der Kern des Geschenkes ist, dass ich voll und ganz die Verantwortung übernehme und mein Liebster sich einmal ganz hingeben darf. Und ich freue mich schon sehr darauf, wenn wir den Spiess irgendwann mal umdrehen. Fülle: Wie oft lassen wir uns Grenzen auferlegen – Zeit, Geld, sexuelle Ausdauer. Fülle entsteht als erstes im Denken, und es gibt einige Möglichkeiten, unser Denken auszutricksen.
Mein Plan sieht im Moment so aus: Ich empfange ihn im Weihnachtsmann-Kostüm – mitsamt falschem Bart – und unter dem Mantel wunderschöne rot-goldene Reizwäsche. Ist das nicht reizend? Noch mit Bart und Mantel werde ich ihn dann fragen, ob er brav war oder nicht – für jede Sünde bekommt er eins mit der Rute, für jede gute Tat ziehen wir ein Kleidungsstück aus, abwechselnd er und ich. Da er alles in allem die Erwartungen der Weihnachtsfrau übertroffen hat, führe ich ihn sodann auf unser Lager. Aber nicht ins Schlafzimmer! Ich nutze den Luxus des Ungestört-Seins und habe unser Wohnzimmer grosszügig arrangiert – unter dem leuchtenden Weihnachtsbaum ein breites Lager mit Kissen, Düften, Farben. Die obligatorische Weihnachtsmusik wird sich Stück für Stück in sinnliche SoulKlänge wandeln.
Gibt es Alkohol? Vielleicht ein ganz klein wenig, gerade genug zum Anregen. Rundherum verteilt liegen viele kleine Geschenke, Leckereien zum Naschen und gegenseitigen Verwöhnen. Jedes Geschenk, das er auspackt, enthält eine Fantasie, eine Botschaft, ein sinnliches Geschenk oder eine erotische Wunscherfüllung. Ich bin mir nicht zu schade, auch eigene Wünsche einzuarbeiten. Da ist zum Beispiel eine Augenklappe und daran steht: «Blind Date». Haben Sie sich schon einmal verwöhnen lassen, ohne etwas sehen zu können? Versuchen Sie es, mehr sage ich hier nicht. Wofür das duftende Massageöl gedacht ist, braucht keine weitere Erklärung. Ein weiterer Zettel sagt: «Eine Stunde lang bist du der Boss.» Usw. Ich war sogar in einem Sexshop und habe mich beraten lassen – kleine Spielzeuge wie der «Satisfyer», ein Penisring und ein GPunkt-Aktivator werden uns entweder Wonnen bereiten oder zum Glucksen bringen. Statt der Weihnachtsgeschichte habe ich eine erotische Geschichte als Hörbuch ausgesucht – da gibt es mittlerweile viele Webseiten mit erotischen Stories, die über den üblichen Porno-Muff herausragen. Und für später habe ich eine leichte Mahlzeit vorbereitet, die ich nach einem «Liebes-Kochbuch» zubereitet habe – abgeschmeckt natürlich mit aphrodisischen Gewürzen wie Safran, Ingwer, Kardamon und Muskatnuss.
Was meinen Sie? Gelingt das Fest? Vielleicht habe ich Sie angeregt, selbst etwas Ähnliches zu versuchen. Mir ist jedenfalls beim Planen schon wohlig zumute geworden. Ich glaube, mein Liebster und ich werden einfach heute schon ein bisschen aneinander naschen. Frohe erotische Weihnachtszeit!
Leila Dregger ist Journalistin und Buchautorin. Sie begeistert sich für gemeinschaftliche Lebensformen, lebte u. a. über 18 Jahre in Tamera, Portugal, sowie in anderen Gemeinschaften. Am meisten liebt sie das Thema Heilung von Liebe und Sexualität sowie neue Wege für das Mann- und Frau-Sein.

Die Pohltherapie verbindet fünf Techniken, um Verspannungen zu lösen und das Bewusstsein für den Körper zu schulen. Chronische Beschwerden können damit nachhaltig behandelt werden.
Lioba Schneemann

Die Fehlhaltungen sind in der Regel den Betroffenen gar nicht bewusst.
Sitze ich entspannt oder neige ich meinen Oberkörper nach vorne? Stehe ich mit durchgedrückten Knien da? Ziehe ich die Schultern hoch, wenn ich am PC sitze? Ziehe ich meinen Bauch ein, um schlanker zu wirken? Wie sind beim Sitzen meine Füsse platziert? Atme ich tief bis in den Bauch oder geht das nicht? Ratsam ist es, zu erforschen, was wir täglich tun. Denn unsere Haltungen, die wir im Alltag und bei der Arbeit vor dem PC einnehmen, führen oft zu Verspannungen und Fehlhaltungen. Ebenso können Verletzungen, Unfälle, traumatische Erfahrungen oder dauerhafter Stress die Ursache für Anspannungen im Körper sein.
Jedoch ist das «Hinspüren» gar nicht so leicht. Denn die Fehlhaltungen sind uns derart in «Fleisch und Blut» übergegangen, dass wir sie gar nicht wahrnehmen. Die Folge sind oft allerlei Beschwerden: Der Rücken, der Nacken oder die Hüfte tun weh, die Schulter schmerzt oder wir haben häufig Bauchschmerzen. Andere Symptome sind Schwindel, Kopfschmerzen, wiederkehrende Migräne, Tinnitus, Übelkeit oder auch Atemstörungen, Kloss im Hals, Taubheitsgefühle, Unruhe und unerklärliche Angst oder gar Panikattacken. Selbst chronische Beckenbodenbeschwerden (etwa Dammschmerzen, Harndrang, Reizblase) haben ihren Ursprung sehr häufig in chronischen Fehlhaltungen.
Detektivarbeit
Oft treten «unspezifische» Beschwerden auf, die schwer einzuordnen sind und chronisch werden, also länger als drei Monate andauern. Betroffene nehmen diverse Behandlungen in Anspruch, gehen mitunter von einer Therapie zur nächsten, manchmal folgt eine Operation –ohne wirklichen Erfolg. Wenn sich dazu noch kein organischer Befund erheben lässt, leidet irgendwann auch die Seele. Ist man wirklich krank? Wieso findet man nichts? Es ist doch etwas nicht in Ordnung! Hilflosigkeit und Hoffnungslosigkeit machen sich breit. Wenn die Beschwerden dann auch als rein psychosomatisch beurteilt
werden, kann sich ein Gefühl des Nicht-ernst-genommen-Werdens einstellen, was dann die körperlichen Beschwerden zusätzlich verstärken kann. Ein Teufelskreis…
Die Pohltherapeutin Anja Gyger aus Thun hat täglich mit solchen Menschen zu tun, die keine dauerhafte Linderung ihrer chronischen Leiden erfahren. Die Sensomotorische Körpertherapie nach Dr. Pohl hat sich gerade dann als hilfreich erwiesen, wenn es keinen organischen Befund gibt für chronische Beschwerden und Schmerzen.
Anja Gyger dazu: «Oft ist es nicht so einfach zu erkennen, wo die Ursachen für diese Symptome sind. Ich muss regelrecht wie eine Detektivin arbeiten.» In der Regel seien es massive Verspannungen und Verhärtungen in der Muskulatur, den Sehnen, Faszien sowie im Bindegewebe der Haut, die sich in verschiedenen Symptomen äusserten. Gleichzeitig sei auch die Körperwahrnehmung durch die Daueranspannung gestört, so dass die Verspannungen nicht als solche wahrgenommen werden könnten. Massagen oder ähnliches helfe dann nicht. «Im Erstgespräch bespreche ich die Alltagsgewohnheiten, und in den folgenden Therapiestunden kommen häufig die Ursachen immer deutlicher zum Vorschein. Auch dadurch, dass die Patient*innen lernen, durch die Lockerung der Verspannungen mehr zu spüren», sagt die Therapeutin.
Die Fehlhaltungen, die zu diesen Dauerkontraktionen führen und worauf der Körper reagiert, sind nämlich in der Regel den Betroffenen gar nicht bewusst. Denn unser Körper und unser Gehirn haben sich an den kontrahierten Zustand gewöhnt. Die Aufgabe der Pohltherapeutin ist es daher, die Aufmerksamkeit darauf zu richten und Zusammenhänge zu erklären. Gyger: «Aus der Art und der Lokalisation der Schmerzen oder Beschwerden kann ich schon vermuten, was die Betroffenen im Alltag tun, wo der Auslöser der
Der Betroffene lernt, zu beobachten, welche Muskeln sich bei welcher Bewegung oder Haltung verspannen.
Anspannungen zu suchen ist.» Durch gemeinsames Erforschen von alltäglichen Haltungen und Bewegungen oder erfahrenen Traumata, komme man der Ursache auf die Schliche.
Die Bewusstmachung und Auflösung der unbewussten Spannungen bzw. des «individuellen Spannungsmusters», das die Betroffenen sich über Jahre angeeignet haben, ist kein rein mentales Vorgehen. Ein Hauptziel der Pohltherapie ist es darum, dass die Menschen lernen, sich selbst zu spüren. Gyger: «Als einen Hauptaspekt der Pohltherapie lernen die Patient*innen mittels Körperbewusstheitstraining, die Entstehung einer Verspannung zu verhindern. Der Mensch gewinnt die bewusste Steuerung seiner Bewegung zurück.»
Die Betroffenen lernen, zu beobachten, welche Muskeln sich bei welcher Bewegung oder Haltung verspannen und wie sie gezielt entspannt werden können. Dazu werden neue Bewegungsabläufe gelernt, die zuhause stetig geübt werden sollten. Aktive Mitarbeit der Betroffenen ist dabei unabdingbar für den Therapieerfolg. Mithilfe der Therapie lernen die Betroffenen, den eigenen Körper und dessen Reaktionen in individuellen Zusammenhängen zu spüren, zu verstehen und zu bewegen. Im Laufe des therapeutischen Prozesses wird das Zusammenspiel zwischen Gehirn, Körper und Bewegung gefördert. Denn im Gehirn – so die These, die sich auf der «Somatics»-Methode von Thomas Hanna stützt – ist eine «Sensomotorische Amnesie» entstanden: Die Hirnteile, die für das Spüren zuständig sind, haben vergessen, wie sich die dauerkontrahierten Muskeln in lockerem Zustand anfühlen und bewegen lassen. Die neurologische Reizweiterleitung und die Feedbackschlaufe zum Gehirn sind aufgrund der fehlenden Bewegung und der Erstarrung gestört. Es sind, bildlich ausgedrückt, «weisse» Flecken auf der Körper-Landkarte entstanden. Die Pohltherapie nutzt die neurophysiologische Tatsache aus, dass die Bewegungsabläufe des Körpers durch die Körperwahrnehmung massgeblich beeinflusst werden.

Die Sensomotorische Körpertherapie nach Dr. Pohl wurde vor rund 25 Jahren von der Psychologischen Psychotherapeutin Helga Pohl in Starnberg bei München entwickelt. Selbst an unerträglichen Rückenschmerzen leidend, fand sie in der Schulmedizin keine Hilfe. Dank ihrem Forschergeist stiess sie auf alternative Methoden wie Feldenkrais, Hanna Somatics, Myogelosen- und Triggerpunktbehandlung sowie Zen-Bodytherapy. Sie studierte die Zusammenhänge von Körper, Haltung und Bewegung und lernte am eigenen Körper funktionelle Anatomie. Heute ist sie beschwerdefrei. Im Grunde handle es sich um ein neues Konzept der Psychosomatik, in dem, wie auf ihrer Webseite «pohltherapie.de» zu lesen ist, «das direkte Erleben, Bewegen und Wahrnehmen des realen Körpers eine zentrale Rolle spielt».
Die Pohltherapie kombiniert verschiedene Methoden, die sich gegenseitig ergänzen. Denn die Erfahrung zeigt, dass ein einzelnes Verfahren oftmals nicht ausreicht, um den komplexen psychophysischen Geschehen bei Schmerz und anderen Beschwerden wirklich Herr zu werden. «Neben der speziellen Behandlung des Bindegewebes kommt die Triggerpunktbehandlung und Pandiculation nach Thomas Hanna zum Einsatz», sagt Anja Gyger. «Darunter versteht man eine Technik, bei der es um aktives Spüren und Bewegen geht. Die Patient*innen lernen, die Muskeln wieder anzusteuern. Das benötigt etwas Übung und die Verspannungen werden weniger.»
Die Schmerzpunkte wie auch das Bindegewebe werden zudem aktiv behandelt. Erst nach der manuellen Auflösung der Kontraktion können die Patient*innen sich wieder spüren. Sensomotorische Übungen werden extrem achtsam und langsam ausgeführt, wobei man genau lernt zu verstehen, warum man etwas wie bewegt. Ziel ist es, dass die betroffenen Körperteile wieder in die normalen Alltagsbewegungen einbezogen werden können. In diesem Sinne hilft die Pohltherapie individuell und nachhaltig.

Die Pohltherapie kombiniert verschiedene Methoden, die sich gegenseitig ergänzen.
«Wir haben den ganzen Menschen im Blick»
Interview: Lioba Schneemann
Anja Gyger ist in Thun als Pohltherapeutin tätig. Im Interview sagt sie, wie die Pohltherapie wirkt und was sie so einzigartig macht.
«natürlich»: Was ist an der Pohltherapie so einzigartig?
Anja Gyger: Die fünf ineinander greifenden Techniken Bindegewebsmassage, Triggerpunktmassage, die Pandiculation, die sensomotorischen Übungen und das Körperbewusstseinstraining machen die Pohltherapie so einzigartig. Wir haben stets den ganzen Menschen mit seiner Haltung im Blick, nicht nur die einzelnen Muskeln oder das Skelett. Um Muskeln und Bindegewebe zu lösen, werden gezielte Griffe angewendet, die sehr tief wirken. In den meisten Fällen wird direkt nach der Behandlung ein deutlich wahrnehmbarer Unterschied gespürt.
Um die Ursache von chronischen Beschwerden zu finden, gehen Sie also fast wie eine Detektivin vor?
Ja. Ich schaue mir sehr genau an, wie der Mensch steht, sitzt und wie er sich im Alltag, beim Arbeiten oder beim Hobby bewegt. Was macht er oder sie, dass diese Beschwerden auftreten und chronisch geworden sind? Ich frage sehr genau nach, um den Ort der Verspannung und dann den Grund herauszufinden (etwa Operationen, Unfälle usw.). Durch das Lösen der Anspannungen wird die Bewegung wieder möglich, und mit dem Körperbewusstseinstraining erhalten die Patient*innen die Beweglichkeit zurück und Fehlhaltungen werden zukünftig vermieden.
Inwiefern haben die Patient*innen grossen Einfluss auf den Therapieverlauf?
Auch hier ist es unabdingbar, dass die Patient*innen aktiv mitmachen. Alle Menschen können mir ziemlich genau zeigen, wo es wehtut, wo der Schmerz sitzt oder auch, wo die Angst spürbar ist. Alles kann im Körper «verortet» werden. Bei nahezu allen «psychosomatischen» oder funktionellen Beschwerden gibt es einen objektiv feststellbaren Befund: Dauerkontraktionen in Muskulatur und Bindegewebe. In der Sitzung werden verspannte Körperpartien gezielt bewegt, Triggerpunkte und Bindegewebe gelockert. Daneben ist es sehr wichtig, dass die Patient*innen zuhause regelmässig gezielte Übungen zur Schulung der Körperwahrnehmung und zum Erhalt der Beweglichkeit machen. Die Menschen lernen im Laufe der Therapie zunehmend, sich selber zu helfen mittels Übungen, Selbstbehandlung und durch das veränderte Körperbewusstsein.
Anja Gyger Pohltherapeutin


Viele Naturvölker setzen den Eigenurin als Heilmittel ein. Hierzulande ist die Eigenharntherapie nur wenig verbreitet. Dabei ist der Urin weit mehr als ein Restprodukt der Körperausscheidung. Noch gibt es dazu jedoch keine wissenschaftlichen Studien.
Fabrice Müller Illustration: Sonja Berger
Urin als Heilmittel einzusetzen, scheint heute vielen Menschen als eine verrückte Idee zu erscheinen. Urin bei Hauterkrankungen einzureiben, das kann man sich vielleicht noch vorstellen. Aber den eigenen Urin zu trinken? Bei diesem Ansinnen wird man wohl bei den meisten Mitmenschen auf Unverständnis stossen. Dabei blickt die Anwendung von Urin für die sogenannte Eigenharntherapie auf eine lange Tradition zurück. In Indien beispielsweise wurde die Therapie angewandt, um den Körper von belasteten Stoffen zu befreien.
Diese Tradition lebt in der indischem Medizin Ayurveda seit 5000 Jahren bis heute fort. Uralten Überlieferungen zufolge gab es Reinigungsrituale mit menschlichem Urin zudem in der chinesischen und persischen Medizin sowie bei vielen Naturvölkern wie bei den Inuits oder den Roma. Auch der griechische Arzt Hippokrates (460–375 v. Chr.) nutzte die Heilkräfte des Urins. Im 20. Jahrhundert kam die Eigenurintherapie zu neuer Bekanntheit, nachdem der Engländer John Armstrong offenbar seine als unheilbar geltende Tuberkulose im Eigenversuch mit Eigenurin kurierte. Von 1997 bis 2016 existierte mit der Deutschen Gesellschaft für Harntherapie (DGH) eine Vereinigung von Lai*innen und Therapeut*innen, die überzeugt waren von der Anwendung der Harn- oder Urintherapie. Die Vereinigung hat umfangreiche Informationen zum Thema Urinanwendungen zusammengestellt. Ausserdem konnten viele Menschen für einen anderen Umgang mit dem eigenen Urin sensibilisiert werden.
Der Bereitschaft, eine Therapie mit dem eigenen Urin durchzuführen, steht bei vielen Menschen eine grosse mentale und gefühlsmässig Hemmschwelle entgegen. «Was zu Hippokrates und Paracelsus Zeiten selbstverständlich war, wird heute unbegründet, ohne Verstand und jegliches medizinische Wissen, mit Schaudern
abgelehnt», schreibt Wolfgang Podmirseg, Heilpraktiker und Fachautor in seiner Arbeit «Eigenharntherapie und psychosoziale Aspekte». Der heutige Verstand assoziiere mit den menschlichen Ausscheidungen nur negative Vorgänge wie Abfall, Ekel, abstossender Geruch, und so weiter.
Wissenschaftlich nicht nachgewiesen
In der heutigen Medizin geniesst die Therapie mit Eigenurin noch eine geringe Bedeutung, wie Urs Schäffler von der Irchelpraxis in Winterthur berichtet. Die naturheilkundlich ausgerichtete Praxis für manuell-energetische Therapie berät unter anderem Patientinnen und Patienten, die sich für eine Eigenurintherapie interessieren. «Die Wirkung von Eigenurin, vor allem bei der inneren Anwendung, ist mangels Studien wissenschaftlich nicht nachgewiesen», begründet Urs Schäffler, betont jedoch: «Ich habe viele positive Erfahrungen vor allem mit der äusseren Anwendung gemacht und kann zu hundert Prozent dazu stehen.» Der Therapeut schätzt an der Urintherapie, dass sie jederzeit verfügbar und einfach anzuwenden ist, auch unterwegs, wenn man keine Medikamente bei sich hat. «Vor allem die äussere Anwendung eignet sich bestens dafür, erste Erfahrungen mit dem Eigenurin zu sammeln.»
«
Auch der griechische Arzt Hippokrates nutzte die Heilkräfte des Urins. »
Zum Beispiel bei Verrenkungen, Prellungen, Wunden:
Wickelpackung aus einem in Harn getränkten Handtuch und einem trockenen Handtuch, das darübergelegt wird. Umwickeln Sie das Körperteil und achten Sie darauf, dass Sie den Wickel feuchtkalt und locker anlegen.
Wichtig: Die Wickel- und Packungshandtücher nach jedem Gebrauch waschen. Nach maximal zehn Anwendungen eine Pause von ein bis zwei Tagen einlegen, damit der Körper die Informationen, die er von aussen erhält, verarbeiten kann.
Mit Teilbädern lassen sich Warzen, Fusspilz, Hühneraugen behandeln. Sie verschwinden innerhalb von zwei bis vier Wochen. Die Teilbäder sollten morgens und abends jeweils für 15 Minuten durchgeführt werden.
Quelle:
Info-Heft 3/2004 der Deutschen Gesellschaft für Harntherapie (DGH), Hans-Peter Burckhard Melches
Urin wird als steriles Restwasser über die Nieren aus dem Blut herausfiltriert. Somit ist Urin ein Teil des Blutes, ein Blutserumkonzentrat, in dem sich Hormone, Enzyme, Mineralien, Salze, Antikörper wie auch Schlacken, Krankheitsprodukte und Toxine ansammeln. Pro Tag produziert der menschliche Körper in der Leber zwischen 20 und 30 Gramm Harnstoff. Dieser gelangt über das Blut in die Niere. Dort wird er herausgefiltert und im Urin ausgeschieden.

Was passiert bei der Urintherapie? Bei der Einnahme des Eigenurins, der unter anderem Mineralstoffe wie Kalzium, Kalium und Natrium sowie Vitamine, Aminosäuren, Hormone und Enzyme enthält, wird ein Reiz im Körper ausgelöst. Dieser wiederum soll den Körper dazu veranlassen, mit einer sogenannten Reizantwort zu reagieren. Auf diese Weise wird das Immunsystem stimuliert und bei der Bekämpfung von verschiedenen Krankheiten künftig besser unterstützt. «Mich fasziniert an der Eigenurintherapie unter anderem die grosse Palette an Einsatzmöglichkeiten», betont Urs Schäffler.
Der Eigenurin kann über verschiedene Arten dem Körper zugefügt werden. Bei der innerlichen Anwendung wird der Eigenharn durch Trinken, Gurgeln, Inhalation, Einlauf sowie als Ohren- oder Nasentropfen eingenommen. Die Einnahme des Eigenurins wird als Kur über mindestens vier Wochen empfohlen. Weiter lässt sich der Eigenurin auch zur Herstellung eines homöopathischen Mittels verwenden. Er wird zu diesem Zwecke zunächst potenziert, das heisst, mit Wasser verdünnt und anschliessend verschüttelt. Dies soll gemäss dem homöopathischen Grundsatz der Substanz eine höhere Wirksamkeit verleihen. Der potenzierte Eigenurin kann oral eingenommen werden. Die innerliche Anwendung hat sich als besonders erfolgreich gegen Rheuma, Magen-Darm-Erkrankungen, Infektionskrankheiten und Atemwegbeschwerden herausgestellt.
Bei Mund-, Zahn- und Sinusitis-Problemen wird Urin zum Spülen und Gurgeln eingesetzt. Dabei saugt der Urin die Flüssigkeit aus den Geweben, mit denen er in Kontakt kommt. Mit dem eingesaugten Wasser werden auch Eiter und Schleim entfernt; die im Urin enthaltenen Enzyme und Hormone wirken entzündungshemmend auf die Schleimhaut. Weiter wird die Eigenurintherapie bei Heuschnupfen empfohlen. Regelmässige Haarpackungen sollen zudem zu einer Revitalisierung des Haarwachstums und zu einer intensiveren Haarfarbe führen.
Morgenurin am wirkungsvollsten
Bei der oralen Einnahme gilt der Morgenurin als besonders wirkungsvoll, da er mit vielen Hormonen gesättigt ist. Dafür sorgen die um diese Zeit aktiven Drüsen wie Hypothalamus oder Hypophyse. Gleichzeitig verzeichnet der Morgenurin über Spitzenwerte der Sekretion von Glykokortikoiden durch die Nebennieren und die Aktivität der Schild- und Bauchspeicheldrüse. Am Nachmittag und Abend dagegen ist der Harn mit Nährstoffen und deren Produkten gesättigt. Somit ändert sich die Zusammensetzung des Urins ständig, abhängig von den Organaktivitäten und vom Stoffwechsel.
Noch mehr Heilerfolge lassen sich gemäss dem deutschen Heilpraktiker Eberhard Waldschmidt aus Herbolzheim (D) erzielen, wenn der Urin eingekocht wird. Diese Methode wird bereits in alten indischen Schriften erwähnt. Der Urin wird in einem Topf auf kleiner Flamme auf etwa einen Viertel seiner Menge eingekocht und abgekühlt. Er entfaltet offenbar eine stark entgiftende Wirkung und wirkt antiparasitär.
Für die äusserliche Anwendung tupft man den Eigenurin unverdünnt auf die Haut – oder er kommt für Um schläge und Bäder zum Einsatz. Hier hilft der Eigenurin laut Urs Schäffler bei verschiedensten Hautkrank heiten und Gelenkbeschwerden, da ihm schmerzlindernde Eigenschaften zugeschrieben werden. Wirksam soll die Therapie zudem gegen Fusspilz, Sonnenbrand und Warzen sein, und auch allgemeiner Juckreiz und Cellulite lassen sich mit Urin anscheinend lindern. Synthetischer Harnstoff, bekannt als Urea, findet sich bereits in vielen Hautpflegeprodukten, ohne dass wohl die meisten Konsumentinnen und Konsumenten sich dessen bewusst sind. Eine positive Wirkung des harnstoffreichen Urins auf die Haut erscheint daher nicht ganz unplausibel.
Professor Dr. Uwe Hobohm von der Universität für angewandte Wissenschaften in Giessen (D) setzt sich unter anderem mit Spontanheilungen bei Krebs auseinander – zum Beispiel im Rahmen einer Urintherapie. «Es gibt einige anekdotische Berichte von Spontanheilungen bei Krebs mit Urintherapie. Von diesen und anderen Fällen bekommt man den Eindruck, dass die Urintherapie ebenfalls eine stimulierende Wirkung auf das Immunsystem hat», sagt Uwe Hobohm, räumt jedoch ein: «Wir befinden uns erst am Anfang auf dem Weg zum wissenschaftlichen Verständnis.» Von der Harnsäure im Urin nimmt man an, dass sie die Zerstörung durch die Peroxid-Radikale verhindert und deshalb den Ursprung einer Krebskrankheit hemmen kann. Wissenschaftliche Studien zur Wirksamkeit von Urin gegen Krebs gibt es allerdings noch keine.
Keimbelastung und Nebenwirkungen Von einer Eigenurintherapie abgeraten wird Personen mit Bluthochdruck, Diabetes, Krebserkrankungen oder einer Schilddrüsenüberfunktion. Auch bei fiebrigen Erkrankungen, schweren Herz-Kreislauf-Beschwerden, Nierenschwäche, Blasenentzündungen, Harnweginfekten und Leberproblemen ist die Eigenurintherapie nicht zu empfehlen. In manchen ärmeren Regionen in Afrika wird die Urintherapie als billiges, leicht ver fügbares traditionelles Heilmittel auch bei kranken Babys und Kindern angewendet. Eine Untersuchung des Urins von gesunden Kindern und Kühen in Nigeria
« Synthetischer Harnstoff, bekannt als Urea, findet sich bereits in vielen Hautpflegeprodukten. »
fand darin eine erhebliche Keimbelastung. Unter anderem konnte das Forschungsteam antibiotikaresistente Keime nachweisen. Zu den möglichen Nebenwirkungen der Eigenharntherapie aufgrund mangelnder Reinheit des Urins oder gar durch Belastungen mit Bakterien und Viren zählen Durchfall, Übelkeit oder Erbrechen, Kopfschmerzen und Müdigkeit.
Zahlreiche Erfolgsmeldungen
Trotz aller Kritik: Als Erfahrungsmedizin scheint die Eigenurintherapie bei vielen Menschen ihre Wirksamkeit bewiesen zu haben. Urs Schäffler von der Irchelpraxis hat von seinen Patient*innen wie auch von externen Personen verschiedene Zuschriften und Erfahrungsberichte rund um die Eigenurintherapie erhalten, zum Beispiel von einem Mann im Alter von 47 Jahren: «Ich trinke seit ca. 15 Jahren täglich meinen Morgenurin. Ausserdem reibe ich meine Haut ein bis zweimal monatlich ein und nehme auch gerne ein Wannenbad, ohne Schampoo, aber mit Urin. Meine Haut ist sehr viel gesünder und geschmeidiger als früher. Durch das Trinken des Urins habe ich keine Grippe mehr, die ich sonst regelmässig einmal im Jahr hatte.» In einer anderen Zuschrift wird folgender Fall geschildert: «Ich hatte immer wieder Schulterschmerzen und war in verschiedenen Behandlungen. Die Kortisonspritze half. Der Arzt meinte, es sei eine Schleimbeutelentzündung. Die Schmerzen kamen aber wieder, zwar nicht mehr so stark wie früher, aber immer noch sehr behindernd. Seit diesem Sommer reibe ich die Schultern morgens mit dem Eigenurin ein. Nach ein paar Wochen gingen die Schmerzen markant zurück.» Bei einer anderen Patientin konnte eine sehr schmerzhafte Schwel lung im Daumengelenk geheilt werden: «Ich machte dreimal täglich Umschläge während 20 Minuten. Die Schwellung ging sofort zurück, ebenso die Schmerzen. In wenigen Tagen konnte ich wieder arbeiten und brauchte auch keine Schmerzmittel mehr.»
www.irchelpraxis.ch/urintherapie-in-derheilkunde

Neunerleiholz sind Holzbündel, die neun verschiedene Hölzer enthalten. Sie dienen dem Schutz vor Krankheiten und symbolisieren die Wärme, die wir im Winter benötigen. Nicht nur im Aussen, auch im Innersten unserer Seele.
Steven Wolf
Eingehüllt in winterliche Kälte, bewegen wir uns auf das Ende des Jahres zu und dringen immer tiefer in die Dunkelheit des Dezembers. Im warmen Kerzenlicht, das die Adventszeit begleitet, hören wir tief in uns hinein und kommen zur Besinnung. Für mich ist diese Zeit des Innehaltens, eine der wichtigsten Phasen im Jahreskreis. Es geht ums Klären, Altes loslassen, Abschiednehmen und ums Abschliessen. Es ist eine Zeit, in der wir uns bereit machen, um über die Schwelle zu schreiten und die Geburt des neuen Lichtes zu feiern, das uns zur Wintersonnenwende, auch Yulfest oder Mutternacht genannt, aus der Dunkelheit erlöst.
Viele Brauchtümer dienen dazu, das Licht, die Wärme und unser inneres Kind zu nähren. Nach Samhain, dem irisch-keltische Fest am 1. November, ist in der alten Tradition nur noch das Holzsammeln erlaubt. Daher finde ich das Sammeln von Holz, insbesondere des Neunerleiholzes, ein sehr schöner Brauch. Genau wie die Holle, die Erdenmutter in der Verkörperung der alten Greisin, machen auch wir uns auf in die Wälder, um Holz zu sammeln. Die Holle benötigt das Holz um alle Seelen, die sie über den Winter hütet, mit lichtvoller Wärme zu nähren. Für unsere Ahn*innen war das Element Feuer ein lebendiges Wesen, das Nahrung und Luft zum Leben benötigt. Sie erkannten, dass je länger ein Feuer brannte, desto mehr wurde es belebt, lebendiger und kräftiger. Das Aufrechterhalten des Herdfeuers, als Sinnbild für das Licht in der Dunkelheit der winterlichen Jahreszeit war daher von grosser Bedeutung. Nichts sollte diese heilige, klärende Zeit stören oder der Wiedergeburt des neuen Weltenlichtes im Innen wie im Aussen im Weg stehen.
Neunerleiholzbündel
Das Neunerleiholz kommt in den Jahreskreisfesten in verschiedenen Variationen zum Einsatz. Stäbe aus verschiedenen Hölzern wurden in die Erde gesteckt, um Ritualplätze zu schützen. Die Neunerleibündel dienten zudem dem Schutz vor Krankheiten, als Räucherwerk, Wetter-, Liebes- und Fruchtbarkeitszauber, Talismann
oder als Notfeuer, wenn das Feuer im Kamin ausging. Das Sammeln von Holz für das Neunerleibündel ist aber nicht einfach ein blosses Holzsammeln, es ist ein Wahrnehmungsritual. Es ist ein Anknüpfen an die Energie des alten, grünen Pfades unserer Ahn*innen, bei dem man mit Gesang, Räucherungen oder Gaben um Einlass in das Reich des Waldes bittet. Respektvoll, schweigend, in der eigenen Stille ruhend und dennoch präsent wird das tote Holz abseits der Wege gesammelt. Während des Winters verwendet man ausschliesslich am Boden liegendes Totholz. Es sollte nichts abgeschnitten werden. Zum Schluss wird das Holz, das aus neun verschiedenen Hölzern besteht, mit einem roten Band neunmal umwickelt, mit neun Knoten verschlossen und beliebig verziert. Ich bitte um den Segen dieser Bündel und beende das Ritual. Traditionell wird vor jedes Fenster ein Bündel angebracht. Aber auch über dem Kamin, den Türen, im Stall, oder auf dem Tisch.
Ein weiterer Name des Neunerleiholzbündels lautet Hexenschemel. Ein Hinweis auf die schützende Funktion des Bündels gegen Unholdenergien oder Energievampiere. Sogar gegen die reitenden Truden, die Nachtalpen oder den Mahrt, alles Geisterwesen, die nachts Ängste, Alpträume, Beklemmungsgefühle, Brust/Kehlendrücken und Atemnot auslösen, sollen die Bündel schützen. Und nicht nur das! Die Bündel schützen auch gegen menschlichen Neid, Missgunst und Beschreiung.
des Neunerleiholzbündels lautet


Die Bedeutung der Zahl Neun Spirituell steht die Neun, drei mal drei, für das Geistige, die Weisheit, die höchste Vollendung, die Vollkommenheit, das göttliche Bewusstsein und das Universum, denn die Vollendung, der Kreis mit einem Radius von 360 Grad, ergibt in seiner Quersumme die Zahl Neun. Neun ist die erste, ungerade, zusammengesetzte Zahl, die keine Primzahl ist. Zudem ist sie die letzte Zahl, die im Dezimalsystem nur eine Ziffer besitzt. Man kann sie mit jeder beliebigen Zahl multiplizieren und die Quersumme wird immer neun ergeben. Die neun ist teilbar durch eins, drei und neun; neun ist 3³. So verstarb auch Jesus in der neunten Stunde. Der Stunde des Löwen, der Besinnung und der höchsten Vollendung.
Die Neun ist eine wichtige Zahl der Transformation. Welche neun Hölzer effektiv im Bündel vorkommen, spielt keine Rolle. Die Holzwahl variiert je nach regionaler Kultur, derer Riten, der Herbalmagie und der Beschaffenheit der jeweiligen Flora. Ich persönlich lasse mich am liebsten von meiner Intuition leiten und finde es äusserst spannend zu beobachten, was einem da so ruft. Jedes Holz hat seinen Charakter und kann mit seinem Wesen unser Leben unterstützen:
Esche: Besitzt ein tiefes Wissen über die Seelengewässer und deren Seelengründe. Sie fliesst tief in die Seelenebenen ein und vermag die an den falschen Stellen gebundenen Knoten zu lösen, um ein zyklisches, harmonisches Band des Lebens zu erstellen. Die Esche verbindet


uns mit der Menschenseele und lehrt uns bei der wahrhaftigen Menschwerdung. Das heisst, sie zeigt uns, was es bedeutet, Mensch zu sein. Dadurch verhilft sie uns zu besonnenen Einsichten und Taten.
Eibe: Das Holz fördert den Ahnenkontakt und die Transformation. Der Tod wird zum Lehrmeister des Lebens. Die Eibe unterstützt somit das Sterben und Loslassen alter Dinge und lässt so die Essenz des Lebens klar hervortreten. Begleitet die Visionen und stärkt das innere Wissen um die Lehre aller Dinge. Vor der Kraft der Eibe, hat kein Zauber/Trugbild bestand.
Fichte/Tanne: Das Holz hilft, uns zu erden, um wieder zur inneren Ruhe und Ausgeglichenheit zu kommen. Das Wachstum, die Lebenskraft, die Entschlossenheit und die Ehrlichkeit werden gefestigt, um stürmische Zeiten besser zu bewältigen. Die Tanne hilft beim Erkennen des eigenen Lichtes und der individuellen Einzigartigkeit. Das Durchlichten, das Empfangen und das Umsetzen des Lebensplanes. So weist uns ihr Wesen den richtigen Weg und gibt Klarheit bei verirrenden, verwirrenden Verstrickungen und Abhängigkeiten.
Hasel: Die Hasel lässt uns auch in der winterlichen Zeit nicht erstarren und fordert auf, uns dem Fluss des Lebens hinzugeben. Die Quelle der Inspiration, der Intuition nicht gefrieren zu lassen, die Tore der Ebenen am Leben zu erhalten und ein besseres Verständnis zur eigenen Traumwelt zu entwickeln. Flexibilität, Beweglichkeit, Leichtigkeit und die Fröhlichkeit sind der Hasel eigen.


Birke: Durch den äusseren und inneren Tanz vertreibt sie die negativen Gedanken und die Winterdepression. Sie verweist uns auf die positiven Aspekte des Lebens. Ihr inneres Kind löst Blockaden in körperlicher und seelischer Hinsicht. Auf das wir beschwingt und mit Energie unsere neuen Taten angehen können.
Eiche: Die Eiche ist ein Sinnbild für Stärke, Mut, Härte und Kraft. Die Wiederstandfähigkeit, das Durchhaltevermögen, die Charakterstärke und der Gerechtigkeitssinn der Eiche wirken aufbauend und anregend auf Geist und Seele. Dadurch steigert sich auch die eigene Konfliktfähigkeit, die Bodenständigkeit sowie die besonnene Friedfertigkeit, um fruchtende Gedankengänge zu vollziehen.
Ahorn: Der lichterne, luftige Charakter ist individuell, fröhlich und voller Leichtigkeit. Das Wesen des Ahorns bestärkt unseren Idealismus, die Freiheitsliebe, die Eigenständigkeit, die Selbstfindung und die Gelassenheit. Der Ahorn erhöht unsere Toleranz gegenüber der Vielseitigkeit. Aber auch unseren kommunikativen, nicht selbstbezogenen Ausdruck für den Ausgleich und die Harmonie.
Buche: Sie desillusioniert, bewegt uns ins Hier und Jetzt und verschafft Abstand vom verkrampften Denken. Sie macht uns geduldiger und ausdauernder beim Annehmen von dem, was ist. Sie erhöht die Toleranz und hilft uns zu akzeptieren, dass wir Andere nicht ändern können und lernen müssen uns selbst so anzunehmen, wie wir sind.


Erle: Das Wesen der Erle steht in sinnlicher Verbindung zu den Emotionen. Das Erlenwesen lehrt uns Standhaftigkeit, Schutz, Verteidigung, innere Stärke und Selbstvertrauen. Sie ist ein schützender Schild, der uns stark und doch gefühlvoll und intuitiv sein lässt. Um den Widrigkeiten des Lebens offen und eigenverantwortlich begegnen zu können. Ein Schild, der dennoch die eigenen Ansichten verteidigt und keine Grenzüberschreitungen zulässt.

Steven Wolf hat schon als Kind von seiner Grossmutter altes Pflanzenwissen gelernt und weiss um die Kraft der Natur mit all ihren sichtbaren und unsichtbaren Wesen. Er lebt in Escholzmatt, wo er zusammen mit seiner Partnerin ganzheitliche Pflanzenkurse für interessierte Menschen durchführt. Im Lochweidli steht dafür eine eigens gebaute Schuljurte. www.pflanzechreis.ch
FOOD WASTE
127 kg Lebensmittel pro Person in der EU verschwendet
In der Europäischen Union wurden im Jahr 2020, rund 127 kg Lebensmittel pro Einwohner*in verschwendet. Dabei waren Haushalte für 55 % der Lebensmittelabfälle verantwortlich, was 70 kg pro EU-Einwohner*in entspricht. In der EU sind die Haushalte für einen Anteil von 55 % des Food Waste verantwortlich. Die restlichen 45 % entfielen auf Abfälle entlang anderer Stationen der Lebensmittelversorgungskette, wie aus einer erstmalig EU-weiten Untersuchung hervorgeht. Die Verringerung der Lebensmittelverschwendung durch Konsumierenden bleibt sowohl in der EU als auch weltweit eine Herausforderung, schreibt Eurostat, das statistische Amt der EU, welches die Ergebnisse veröffentlichte. Demnach sind die Lebensmittelabfälle der Haushalte fast doppelt so hoch wie die Lebensmittelabfälle, die in den Sektoren Primärproduktion (14 kg bzw. 11 % pro EU-Einwohner*in) und Herstellung von Lebensmitteln und Getränken (23 kg bzw. 18 %) anfallen. Auf Restaurants und Gastronomiebetriebe entfielen 12 kg Lebensmittelabfälle pro Person (9 %), während der Einzelhandel und sonstige Lebensmittelvertriebe jene Bereiche mit der geringsten Menge an Lebensmittelabfällen waren (9 kg bzw. 7 %). ska

Katzen erkennen an sie gerichtete Sprache
«Bis später!», oder «wie geht es dir?»: Diese Äusserungen klingen etwas anders, wenn sie jemand zu seiner Katze oder aber zu einem Mitmenschen sagt. Für diese Unterschiede haben Katzen offenbar eine feine Wahrnehmungsfähigkeit, legen Ergebnisse einer experimentellen Studie nahe, welche von «wissenschaft.de» publiziert wurde. Was ihre Besitzer*innen betrifft, können die Tiere demnach an sie adressierte Sprache von an Menschen gerichteten Äusserungen unterscheiden. Dies spiegelt sich dabei in auffälligen Verhaltensmustern wider. Es handelt sich um einen weiteren Hinweis dafür, in welch subtiler Weise sich auch Katzen auf ihre menschlichen Bezugspersonen einstellen, sagen die Forschenden. ska



Drei Viertel der Schweizerinnen und Schweizer sind laut einer Umfrage besorgt über den Plastikmüll in Meeren und an Stränden. Mehr als die Hälfte der Bevölkerung wünscht sich harte Massnahmen und Interventionen per Gesetz gegen diese Verschmutzung. Dies geht aus einer Umfrage der NGO Oceancare hervor. Die internationale Organisation mit Sitz in der Schweiz setzt sich für ein globales Plastikabkommen für die Eindämmung von Plastik ein. Das grösste Problem sehen die Schweizerinnen und Schweizer gemäss der vom Forschungsinstitut gfs.bern durchgeführten Umfrage bei Plastikverpackungen. Besonders Doppelverpackungen gelten als unnötig (34 Prozent), generell werde «zu viel verpackt» (30 Prozent). Interessanterweise habe sich gezeigt, dass das Plastikproblem vor allem der älteren Generation grosse Sorgen mache. Dies sei anders als in den meisten öffentlichen Klimadebatten, die stark von jüngeren Akteur*innen angetrieben würden. ska


BEA-Verlag, 5200 Brugg 056 444 22 22, bea-verlag.ch

Martini-Sommer
Im Winter ist es in tiefen Lagen oft trüb, während es in den Bergen sonnig und warm ist. Die Ursache dafür ist der Nebel, der uns häufig aufs Gemüt drückt, besonders dann, wenn wir uns unterhalb dieser seltsamen Wolke befinden, die am Boden aufliegt. Es ist jeweils ein überraschendes Erlebnis, wenn man aus dem trüben und kalten Nebel in die Berge wandert und sich plötzlich in einer warmen und sonnigen Umgebung wieder findet. In den kurzen Wintertagen ist die Sonne für uns besonders wichtig. Deshalb ist ein Spaziergang über dem Nebel Balsam für die Seele und tut in jeder Hinsicht gut. Zudem bietet der Aufenthalt über dem Nebelmeer einen fantastischen Ausblick und lässt die Landschaft wie in einem Märchen erscheinen. Tatsächlich ist das Nebelmeer ein See aus kalter Luft, der die Täler und Senken auffüllt und worin die Feuchtigkeit schliesslich als Nebel auskondensiert.
Der Dezember ist auch eine Zeit der Besinnung und gibt Anlass zu einem Rückblick auf das vergangene Jahr. Es ist Zeit, Altes loszulassen und Neues zu beginnen. Der Aufenthalt über dem Nebel gibt uns auch die Gelegenheit, Energie zu tanken und die Alltagssorgen zurückzulassen, ähnlich wie es im Lied von Reinhard Mey heisst:
«Über den Wolken muss die Freiheit wohl grenzenlos sein. Alle Ängste, alle Sorgen, sagt man, Blieben darunter verborgen und dann Würde, was uns gross und wichtig erscheint, Plötzlich nichtig und klein.»
Andreas Walker


Schule für Sterbe- und Trauerbegleitung
Berufsbegleitende ein- oder zweistufige Ausbildung mit namhaften Gastdozenten:
Anouk Claes, Rosanna Abbruzzese, Dolly Röschli, Kurt Nägeli, Antoinette Bärtsch, Pete Kaupp, Renate von Ballmoos, Marcel Briand, Karin Jana Beck, Nel Houtman, Kokopelli Guadarrama, u.a.
Rosanna Abbruzzese, Dolly Röschli, Kurt Nägeli, Antoinette Bärtsch, Pete Kaupp, Renate von Ballmoos, Marcel Briand, Karin Jana Beck, Nel Houtman, Kokopelli Guadarrama, u. a.
Nächster Ausbildungsbeginn: Samstag, 27. März 2021
Nächster Ausbildungsbeginn: Samstag/Sonntag 25./26. März 2023
«Die Tränen der Freude und der Trauer fliessen aus derselben Quelle»
«Die Tränen der Freude und der Trauer fliessen aus derselben Quelle»
Zentrum Jemanja
Zentrum Jemanja
Ifangstrasse 3, Maugwil 9552 Bronschhofen Telefon 071 911 03 67 info@jemanja.ch www.jemanja.ch
Ifangstrasse 3, Maugwil 9552 Bronschhofen Tel. 071 911 03 67 info@jemanja.ch www.jemanja.ch
Der Mars erreicht am 8. Dezember seine Opposition zur Sonne, das heisst, die drei Himmelskörper Sonne, Erde und Mars befinden sich dann genau in einer Linie. Damit kommt der Mars auf seiner Umlaufbahn der Erde am nächsten und ist dann «nur» noch 81 Millionen Kilometer von unserem Planeten entfernt.
Exakt zur Zeit der Opposition wird der Mars durch den Vollmond bedeckt werden. Wenige Minuten vor der Marsbedeckung sieht die Stellung von Mars und Mond etwa so aus, wie auf dem Bild – der orange Mars nähert sich dem Mond. Um 6.08 Uhr berührt der Mars den Mondrand links oben und wird schliesslich vom Mond «verschluckt» werden. Es dauert etwa 30 Sekunden, bis der Mars vollständig vom Mond bedeckt sein wird. Um 7.04 Uhr taucht der Mars am unteren rechten Mondrand wieder auf. Zu diesem Zeitpunkt steht der Mond bereits relativ tief am Horizont und im Südosten hat die Dämmerung begonnen. Das kosmische Schauspiel ist von blossem Auge sichtbar, ein Feldstecher oder Teleskop leistet bereits gute Dienste.
Um die Bedeckung des Mars vom Mond beobachten zu können, ist es wichtig in Richtung Westnordwesten freie Sicht auf den Mond zu haben. Sollte am Morgen Nebel liegen in tiefen Lagen, ist es notwendig, einen erhöhten Standort über dem Nebel aufzusuchen, um das kosmische Schauspiel geniessen zu können.
Andreas Walker
Dreht die Welt öfter um

NEHMT EUCH ZEIT
… und schenkt euch kleine Glücksmomente.
Mit Kneipp. Baden und so viel mehr.






Unsere Natur ist enorm vielfältig. Diese Vielfalt ist jedoch auch unter Druck. Wir können im eigenen Garten selbst dazu beitragen, dass eine möglichst hohe Biodiversität erhalten bleibt.
Gabriela Gerber
Im Dezember, wenn die Natur in ihrer wohlverdienten Winterruhe steht, ist die beste Zeit, sich Gedanken rund ums kommende Gartenjahr zu machen. Begriffe wie Klimawandel, Treibhauseffekt, Erderwärmung, Umweltzerstörung und Biodiversität werden uns auch im neuen Jahr beschäftigen. Ansporn genug, über Versäumnisse nachzudenken, jedoch nicht zu spät, unserer faszinierenden Flora und Fauna mehr Aufmerksamkeit zu schenken. Ich ermuntere Sie dazu, im Kleinen damit anzufangen und Insekten, Spinnentieren, Amphibien, Reptilien und Vögeln im neuen Jahr etwas zurückzugeben. In Ihrem Garten oder auf Ihrem Balkon können Sie einiges richtig machen, um natürliche Lebensräume für kleine Tiere und Mikroorganismen zu schaffen.
Wir Schweizer*innen zählen bezüglich Reinigung bekanntlich zu den Weltmeister*innen. Für das allgemeine Wohlbefinden ist regelmässiges Putzen zu Hause keinesfalls schlecht. Dass wir mit unserem Putzfimmel aber gerade im Garten viele Biotope von Kleintieren zerstören, ist vielen nicht bewusst. Dazu
gehört zum Beispiel der falsche Schnittzeitpunkt von Stauden oder Wildwiesen, emsiges Kehren von Flächen, akribisches Abführen von farbigen Blättern aus dem Garten im Herbst und das Zupfen von vermeintlichen Unkräutern. Und einige von uns haben den Drang, aus Zeitgründen sofort zum Laubbläser zu greifen. Viele dieser Aktivitäten können Sie sich sparen oder zumindest der Natur zuliebe den richtigen Zeitpunkt oder Einsatzort dazu wählen. Es ist an der Zeit, das kommende Jahr zu planen. Indem Sie nützliche und artgerechte Unterschlüpfe errichten, tragen Sie wesentlich dazu bei, kleine Lebewesen zu fördern und zu schützen. Wie aber können Sie vielen Tieren helfen?
Bauen von Unterschlüpfen
Mauern und Haufen aus eckigen oder runden Steinen sind sowohl sehr hübsche Gartenobjekte als auch perfekte Behausungen für Reptilien, Spinnen und viele Insekten. Gerne sonnt sich hier beispielsweise die einheimische Zauneidechse oder die ungiftige und für Menschen harmlose, einheimische Schlingnatter.

Behausungen für Reptilien

Zauneidechse
Sandlinsen
Drei von vier einheimischen Wildbienenarten nisten in selbstgegrabenen Gängen im Boden. Eine an sonniger Lage angelegte Sandlinse bietet dazu beste Voraussetzungen. Zum Bauen einer solchen eignet sich zum Beispiel spezieller Wildbienensand der Firma Ricoter. Gewöhnlicher Spielkastensand, der zum Verkauf angeboten wird, ist gewaschen und enthält zudem keinen Lehm mehr, was für die Wildbienen von Bedeutung ist. In der Schweiz gibt es über 600 Wildbienenarten. Sie gehören zu den wichtigsten Bestäubern.

Asthaufen und Totholzstellen
Schnittgut von Gehölzen wird am besten an windstillen, sonnigen und ungestörten Ecken im Garten geschichtet. Dort werden die Asthaufen ganz der Natur überlassen. Sie bieten Igeln, Würmern, Blindschleichen, Kröten, Eidechsen, Fledermäusen und Vögeln perfekten Unterschlupf. Da das Material auf natürliche Art verrottet und von Kleinstlebewesen (Mikroorganismen) zersetzt wird, schichtet man von Jahr zu Jahr wieder neues Material obendrauf.
In morschem Totholz, beispielsweise Baumstrünken, fühlen sich Käfer, Larven, Tausendfüssler, Spinnen, Milben, aber auch Wildbienen wohl. Die in der Schweiz als gefährdet geltende, blaue Holzbiene ist die grösste einheimische Wildbienenart. Mit ihrer Körperlänge von 28 mm bohrt sie kleine Höhlen in morsches Totholz, wo sie ihre Brut aufzieht. Sie besucht auf der Nektarsuche gerne Schmetterlings-, Korb- und Lippenblütler.


Ohrwurmbehausungen und Insektenhotels
Ganz einfach selbst basteln können Sie eine Behausung für Ohrwürmer. Benutzen Sie dazu einen alten Tontopf und stopfen Sie ihn mit Holzwolle aus. Bohren Sie den Tontopf viermal an und stecken Sie zwei Holzstäbchen durch. So fällt die Holzwolle nicht heraus. Hier fühlt sich der Ohrwurm besonders wohl. Dieses Insekt ernährt sich nebst anderer Nahrung von Blattläusen. Auch einfach in der Herstellung sind kleine Insektenhotels aus Holzrugeln. Ich habe es in meinem Garten selbst ausprobiert. Mit ein paar Bohrungen in einen Holzrugel ermöglichen Sie Wildbienen kleine Niststätten für ihre Eiablage. Achten Sie unbedingt darauf, dass die Bohrungen sauber sind und sich darin weder Holzspäne noch Splitter befinden. Die Wildbienen könnten sich verletzen. Nur wenige Tage nach der Montage in meinem Garten hat eine Holzschneiderbiene ihre Brut abgelegt und den Ausgang mit einem Pfropfen aus Blattmaterial geschlossen. Ein wahres Wunder der Natur. Der Bau eines Insektenhotels, ob gross oder klein, ist eine sinnvolle Freizeitbeschäftigung.


Oft entscheidet der richtige Moment unserer Eingriffe in die Natur über Leben, Tod oder gar Aussterben von Insekten. Dürres Staudenmaterial wird von unzähligen Käferarten als Überwinterungsdecke genutzt. Es macht aber Sinn, kranke Pflanzenteile von Stauden schon im Herbst zu entfernen, um die Übertragung von Krankheiten für das kommende Jahr zu verhindern. Spriessen im Frühling Schneeglöckchen und Winterlinge, ist es an der Zeit, Schafgarben, Disteln, Sterndolden, Salbei und Gräser handbreit über dem Boden abzuschneiden. Wenn Sie die Möglichkeit dazu haben, erstellen Sie im Garten mit dem Schnittgut vorerst ein Zwischendepot. Es kann später im Jahr, wenn z. B. der Schwalbenschwanz im Mai geschlüpft ist, immer noch der Grüngutentsorgung beigefügt werden. Wenn Sie sich zu den Glücklichen zählen, eigenen Umschwung pflegen zu dürfen, rege ich Sie dazu an, Stauden – und darunter versteht man nicht Gehölze, sondern winterharte, mehrjährige, krautige und nicht verholzende Pflanzen – erst im Frühjahr zurückzuschneiden. Bedenkt man, dass
fast die Hälfte unserer einheimischen Schmetterlinge als Puppe angebunden an Pflanzenstengeln oder in abgestorbenen Streuschichten am Boden überwintert, macht dieses Vorgehen Sinn. Mehrjährige Gräser, im Herbst zu hübschen Skulpturen zusammengebunden, zieren Ihren Garten den ganzen Winter über und bieten zudem dem einen oder anderen Insekt eine perfekte Überwinterungsmöglichkeit. Viele Insekten sind als Bestäuber unentbehrlich, z. B. viele Schwebfliegenarten.


Ein Ehrenplatz gebührt hier der grossen Brennnessel. Sie sollte an einem halbschattigen Platz im Garten unbedingt stehen gelassen werden. Sie wird von vielen einheimischen Schmetterlingen wie vom Admiral, vom Tagpfauenauge, vom Distelfalter, vom Kleinen Fuchs und vielen mehr als Futterquelle bevorzugt. Man trifft diese wunderschönen Schmetterlinge in den letzten Jahren nicht grundlos eher selten an. Die grosse Brennnessel wird zu Unrecht als «Unkraut» degradiert. Auch Blattläuse sind bei uns Menschen nicht unbedingt willkommen. Gerade die Brennnesseln zapfen sie gerne an, weil sie deren Pflanzensaft lieben. Und hier kann man ihnen freien Lauf lassen. Wenn Sie nicht sofort zu Spritzmitteln greifen, tauchen bald Marienkäfer auf, die pro Tag nicht weniger als 50 Blattläuse vertilgen. Bis sich die Larve des Marienkäfers verpuppt, frisst sie bis zu 400 – 600 Blattläuse. Die grosse Brennnessel trägt einen wesentlichen Beitrag zu einem geschlossenen Kreislauf bei, weshalb sie meines Erachtens punktuell unbedingt stehengelassen werden sollte.


Wildblumen und Vogelbad
Ich persönlich bevorzuge einen insektenfreundlichen Rasen. In meinem, auch von vielen Vogelarten besuchten Garten, lasse ich beim Rasenmähen absichtlich Wiesenschaumkraut, Günsel, Braunelle, Gundermann oder Weissklee in Inseln stehen. Sie werden fasziniert beobachten können, wie diese Blumen von Schmetterlingen wie z. B. dem Aurorafalter, von Honig- und Wildbienen, Hummeln und Schwebfliegen zur Nektargewinnung besucht werden. Eine entspannende Freizeitbeschäftigung, zumindest aus meiner Sicht. Zu Unrecht werden viele hübschen Blume im Rasen nicht toleriert. Sollten Sie keinen eigenen Rasen oder Garten haben, können Sie Wildblumen z. B. auch in einen Topf auf Ihrem Balkon aussäen. Lassen sie den Topf den Winter über stehen. Vögel holen sich dort gerne Samen, z. B. die der Sonnenblume.

Die Möglichkeiten zur Erhaltung einheimischer Pflanzen- und Tierarten sind unendlich und hier längst nicht alle aufgeführt. Ich ermuntere Sie in allererster Linie dazu, sei es im Garten oder auf dem Balkon, nicht immer sofort zu chemischen Spritzmitteln, zur Schere oder zum Besen zu greifen. Falllaub im Herbst sollten Sie mit Bedacht zusammenkehren. Überdenken Sie den Griff zum Laubbläser. Sie nerven damit vermutlich nicht nur Ihre Nachbar*innen, sondern zerstören Lebensräume vieler Käfer, Asseln, Tausendfüssler und Spinnen, vor allem durch den Einsatz des Laubbläsers auf Wiesen und unter Bäumen. Sofern Sie genug Platz in Ihrem Garten haben, tragen Sie das Laub besser mit dem Laubrechen zu einem Haufen in einer ungestörten Ecke zusammen. Der Igel schätzt grosse Laubhaufen, sie bieten ihm das perfekte Bett zum Winterschlaf. Ich wünsche Ihnen ein erfolgreiches, gesundes neues Gartenjahr und bestärke Sie darin, dem Begriff «Biodiversität» im kommenden Jahr besonders viel Aufmerksamkeit zu schenken, sollten Sie dies nicht schon längst tun.

Gabriela Gerber, ist gelernte Staudengärtnerin, kaufm. Angestellte und dipl. Arbeitsagogin. Sie ist als Berufsbildnerin in der Vorlehre Integration an der Gartenbauschule Oeschberg in Koppigen BE tätig. In ihrer Freizeit sammelt sie gerne Pilze, kocht gerne und liebt die Natur.

Italianità an der ligurischen Küste! Camogli lädt zum Träumen ein: wo einst grosse Seefahrer zu Entdeckungsfahrten aufbrachen, werden wir entdecken, was Farbe, Pinsel und Stift alles können. Das Fischerstädtchen leuchtet in allen warmen mediterranen Farben und schmiegt sich mit seinen stattlichen Seefahrerhäusern an den Monte di Portofino, ein Naturschutzgebiet von grosser landschaftlicher Schönheit. Zum Aperitivo trifft man sich an der idyllischen Promenade. Oder schaut im Abendlicht mit einem feinen Gelato zu, wie die kleinen Fischerboote ausfahren. Das Meer lockt zum Baden und unser Hotel liegt nur wenige Schritte vom Strand entfernt.
Hier, in dieser mediterraner Gartenlandschaft mit ihren wilden Küstenabschnitten und der erblühenden Macchia, liegen die künstlerischen Motive für Anfänger und Fortgeschrittene direkt vor der Haustüre. Nora Dreissigacker, Malerin zwischen Zürich und Genua, kennt die Gegend um Camogli bestens. Und: Sie weiss, wie man zur eigenen Inspiration und zur eigenen Schaffenskraft findet – und wie man Menschen auf der Suche nach dem eigenen Motiv unterstützt.
1.Tag Zürich–Camogli
Direktzug von Zürich bis Genua, wo Sie die Reiseleitung begrüsst und für das letzte Stück bis Camogli begleitet.
2. bis 6. Tag Perspektiven und Strand
Mit Schiff oder Bus erkunden wir in kurzen Ausflügen die nähere Umgebung und werden den Wechsel vom lebendigen Städtchen zur absoluten Ruhe in der Natur geniessen.
Vielleicht entsteht die eine oder andere Skizze an einem Bartischchen, von wo aus wir das Treiben in den Gassen festhalten. Oder wir sitzen hoch oben über dem Golfo Paradiso mit weitem Blick übers Meer und schwelgen in Klängen von Blau.
Ein Höhepunkt wird die Schifffahrt nach San Fruttuoso sein, die idyllische Benediktinerabtei in einer abgeschiedenen Bucht des Monte di Portofino.
7. Tag Rückreise in die Schweiz
Transfer nach Genua und anschliessend Direktzug bis Zürich. Programmänderungen vorbehalten!

Kursleiterin
Nora Dreissigacker
Kursinhalt
Anfänger und Fortgeschrittene sind herzlich willkommen, … ... «da ich sehr individuell arbeite und versuche, bei jedem Einzelnen das ureigene Potential zu fördern», sagt Kursleiterin Nora Dreissigacker. «Je nach Bedürfnis kann dies in Hilfestellung bei Perspektivproblemen, Farbenlehre aber auch in Gesprächen über Bildwirkung und Bildkomposition stattfinden. Mit Aquarell, Acryl oder Zeichenstiften fangen wir den Frühling an dieser reizvollen Küste ein und finden zu unser ureigenen Bildsprache.»
Weitere Informationen: www.noradreissigacker.com
Auf einen Blick
Die Unterkunft: Das 3-Sterne-Hotel Camogliese mitten im mittelalterlichen Städchen Camogli bietet viel Italianità. Es stehen komfortable Doppelzimmer mit Dusche/WC zur Verfügung. Der Strand ist nur 50 Meter entfernt. Es handelt sich um einen Steinstrand, Badeschuhe sind empfehlenswert.
Reisetermin: 20. Mai bis 26. Mai 2023
Reisedauer: 7 Tage
Teilnehmer: maximal 14 Webcode: 591
Preis:
Doppelzimmer: Fr. 1960.–Zuschlag Einzelzimmer: Fr. 190.–
Im Preis inbegriffen:
• Bahnfahrt ab Wohnort Schweiz in 1. Klasse
• Reservierte Plätze ab Gruppenabfahrtsort Zürich
• Unterkunft inkl. Halbpension
• Trinkgelder im Hotel/in Restaurants
• Transfers und Ausflüge
• Eintritte und Besichtigungen
• Baumeler-Kursleitung/Reiseleitung
• Reisedokumentation
• Hotel 50 m vom Strand entfernt
Beratung und Buchung Markus Kellenberger Tel. 033 334 50 11 (Mo, Di, Mi) reisen@natuerlich-online.ch


Ein Angebot von «natürlich» in Zusammenarbeit mit Baumeler Reisen AG
Baumeler Reisen und «natürlich» – zwei starke Partner arbeiten zusammen und bieten «natürlich»-Leserinnen und -Lesern neu spannende Reisen zu vorteilhaften Preisen an.

Wer sehnt sich nicht nach einer entspannenden Auszeit während der kühlen Jahreszeit? Die grösste Thermenlandschaft des Kontinents in Bad Füssing bietet beste Voraussetzungen hierfür.
Elisha Nicolas Schuetz
Bad Füssing gehört dank seiner drei Thermen zur obersten Liga von Europas Heilbädern. Das Thermalwasser tritt hier mit einer Austrittstemperatur von 56 Grad Celsius aus 1000 Metern Tiefe aus und hat einen PH-Wert von 7,2; dabei spürt man sehr deutlich, dass das Thermalwasser wertvolle Mineralstoffe enthält, die dem Körper guttun – und nicht mit dem Wasser in einem Schwimmbad vergleichbar ist. Thermal- und Mineralquellen sowie Natursole sind angereichert mit den Schätzen des Erdinnern und sind Gesundheitsoasen zum Entspannen und Geniessen. Durch die einzigartige Zusammensetzung aus Mineralien, gelösten Salzen und Schwefel eignet es sich ideal für verschiedenste Badeund Heilzwecke. Dementsprechend ist der natürliche Well-being-Schatz bis heute Gästemagnet Nummer 1 des Kurortes an der bayerisch-österreichischen Grenze.
12 000 Quadratmeter Wasserfläche
Deutschlands beliebtestes Wellness-Reiseziel im Herzen des «Bayerischen Thermenlands» eröffnet Gästen eine unvergleichliche Vielfalt – und ist von der Schweiz aus unkompliziert und schnell erreichbar. In den drei
Thermen erwartet die Gäste eine Erlebniswelt mit rund 12 000 Quadratmetern Wasserfläche. Hier ist es in der Tat ein Leichtes, neue Energie zu tanken – beispielsweise in der Therme Eins mit dem Saunahof, der Europa Therme oder dem Johannesbad. Auch die zahlreichen Hotels verfügen über herrliche Thermenlandschaften zum Entspannen.
Die Geburtsstunde als Kurort
Der Entdeckung der wertvollen Heilquelle stand – wie so oft – der Zufall Pate. 150 Meter vom Bauernhof der Familie Wimmer (heute Ortner-Zwicklbauer) entfernt begannen im Herbst 1937 Bohrarbeiten auf ihrem Acker – zwecks Ölsuche. Statt Öl sprudelte 1938 aber das heisse Schwefelwasser aus dem Boden. Ein wahrer Glücksfall, denn unter den Schwefelquellen in ganz Europa enthält die Therme Eins in Bad Füssing das schwefelhaltigste Wasser. Dies bedeutete die Geburtsstunde Bad Füssings als Kur- und Wellnessort. Als nach dem Zweiten Weltkrieg vermehrt Kurgäste den Ort besuchten, vermietete die Familie 1948 erstmals Zimmer auf dem damaligen Hof. Und da sie auch Eigentümerin der mittlerweile als Therme Eins bekannten Thermalquelle ist, nahm die Erfolgsgeschichte ihren Lauf.

Bad Füssing will den Kur- und Heilwald künftig als zweite «Quelle der Gesundheit» erlebbar machen.
Hervorragende Wellnessoase
Mittlerweile haben sich gleich mehrere Hotels als einige der besten Wellnessoasen Deutschlands etabliert. Kein Wunder, schliesslich verfügen sie nicht nur über das wertvolle Heilwasser, sondern trumpfen mit Pools, Aussenpools, Event-Thermal-Hallenbäder, Whirlpools, Thermal-Bewegungsbäder, Sky-Sole-Infinity-Pools oder Sky-Thermal-Whirlpools gross auf – und werden teilweise mit einer hoteleigenen quellfrischen Thermalquelle gespeist.
Achtsamkeit im Wald
Bad Füssing will den Kur- und Heilwald – neben dem Thermalwasser – künftig als zweite «Quelle der Gesundheit» erlebbar machen sowie spezielle Outdoor-Therapieangebote und das Heilwasser zu ganzheitlichen Gesundheitserlebnissen kombinieren. Denn: Wer in den Wald eintaucht, tut etwas für seine Gesundheit.
Draussen sein, die Atmosphäre des Waldes auf sich wirken lassen und der Stille zu lauschen hat eine beruhigende Wirkung und hilft, sich schneller zu regenerieren. Bad Füssing überrascht mit unzähligen Möglichkeiten, bei einem Waldbad Balance und Ruhe zu finden oder auch bei einer Waldmeditation die Sorgen des Alltags weit hinter sich zu lassen. Auch deshalb ist Bad Füssing Teil des vom Bayerischen Heilbäder-Verband initiierten Pilotprojekts «Wald und Gesundheit».
Spaziergang für die Sinne
Speziell ausgebildete Waldtherapeut*innen und Waldgesundheitstrainer*innen begleiten die Bad Füssinger Gäste künftig auf dem Weg zu Regeneration, Entspannung und neuer Gesundheit. Waldtherapie heisst dabei, dass Bad Füssing die Kraft des Walds als Quelle der Gesundheit, medizinisch fundiert, erlebbar macht.
Dazu zählen beispielsweise Bewegungsübungen und Achtsamkeitsübungen, aber auch Übungen für die Sinne und Atemübungen. So stehen unter anderem ein «Spaziergang für die Sinne» durch den Kur- und Heilwald Bad Füssing und eine Veranstaltung unter der Überschrift «Achtsamkeit im Wald» auf dem Programm.

Bad Füssing ist das beliebteste Wellness-Reiseziel in Deutschland.
Durch die «Bayrische Toskana»
Zudem lässt es sich in der prächtigen Natur der Region herrlich Wandern und Velofahren – mehr als 460 Kilometer bestens ausgebauter Wege erwarten die Besucher*Innen. Bad Füssing garantiert ein unbeschwertes, autofreies E-Bike- und Velovergnügen durch die «Bayerische Toskana» und die Option zum Einstieg in den beliebten DonauRadweg von Passau nach Wien. Weitere schöne Optionen bieten der Inntal-, der Rottal- und der geschichtsträchtige Römerradweg. Diese bestens ausgebauten Velowege und die Direktanbindung an die beliebtesten deutschen FernRadtouren machen Bad Füssing zunehmend auch für Biker*innen interessant. Und was gibt es Schöneres, als anschliessend im wohlig-warmen Thermalwasser Bad Füssings die müden Glieder zu entspannen?
Zwei Drittel des Ortsgebiets sind übrigens öffentliche Parks und Grünanlagen – grüne Lungen und Ruhepole zum Ausspannen und Abschalten. Und dies alles umgeben von sage und schreibe 30 Millionen Blüten im Bad Füssinger Kurpark, einer wahren Oase, wo man gemütlich schlendern und insbesondere im Frühling die immense Blumenpracht bestaunen kann. Hier könnten die Besucher*innen stundenlang verweilen und neue Energie tanken.
Kulinarische Erlebnisse aus aller Welt kommen derweil nicht zu kurz und lassen garantiert keine Wünsche offen. Der Kurort bietet Unterhaltung auf Grossstadtniveau mit Show-Events, weltbekannten Orchestern und Schauspiel- und Opernensembles internationaler Theater sowie einer eigenen Spielbank. Kein Wunder, hat das Magazin «Focus» Bad Füssing fünf Mal in Folge als «Top-Kurort» ausgezeichnet. So bietet sich abends ein Konzertbesuch des Kurorchesters an; es ist in den über fünf Jahrzehnten seines Bestehens zu einer echten Bad Füssinger Institution geworden. Wer mag, versucht anschliessend noch sein Glück im örtlichen Spielcasino, bevor der Gast in einem der zahlreichen Hotels den verdienten Schlaf geniesst. www.badfuessing.com/de/schweiz

Für einen gesunden Rücken sind richtige Haltung und harmonische Bewegungen beim Langlaufen sehr wichtig.
Pontresina im Oberengadin gilt als Mekka für Langläufer*innen. Die ideal präparierten Loipen bieten für jedes Leistungsniveau die passende Strecke – perfekte Gleitpassagen, abenteuerliche Abfahrten, kräfteraubende Waldaufstiege und sogar einen LanglaufConcierge namens Gian Flurin.
Silvia Schaub
Einfach cool, dass man in Pontresina in alle Himmelsrichtungen ausschwärmen kann», sagt Langlauf-Crack Gian Flurin Pfäffli und strahlt. Egal, welchen Schwierigkeitsgrad er auf der Loipe gerade absolvieren möchte, es gibt hier in dieser Seenlandschaft und den Seitentälern immer die richtige Route dazu. Nicht nur für den Spitzensportler aus der Oberengadiner Feriendestination. Pontresina ist ein wahres Mekka für Langläuferinnen und Langläufer jeglichen Niveaus. Über 240 Kilometer umfasst das Loipennetz von Engadin St. Moritz, das auf den schmalen Latten befahren werden kann.
Im Moment ist Gian Flurin noch auf den Rollskiern unterwegs – an fünf Tagen in der Woche während rund fünf Stunden. Als Mitglied des Bündner Skiverbands IBEX hat er sich auf den klassischen Stil spezialisiert und läuft die grossen Langlauf-Klassiker Europas, wie den Vasa-Lauf oder die Diagonela im Engadin. Sobald genügend Schnee liegt, wird er aber auch hin und wieder auf der Loipe beim Langlaufzentrum unterhalb des Bahnhofs Pontresina stehen – und für manche
Langläufer*innen wie ein Geschenk des Himmels sein. Der 26-Jährige ist nämlich auch ein «Langlauf-Concierge» – eine Novität in der Schweiz. In dieser Funktion begrüsst er nicht nur Erstbesucherinnen und Langlauf-Neueinsteiger, sondern gibt auch gerne Tipps oder Tricks mit auf den Weg. Dann erklärt er zum Beispiel einer Langlauf-Anfängerin, wie man den Diagonalschritt richtig ausführt. «Mit der linken Hand erfolgt der Stockeinsatz gleichzeitig mit dem Abstossen des rechten Fusses vom Boden und andersrum.» Klingt logisch und einfach. Doch der Student für Elektrotechnik stellt häufig fest, dass die korrekte Koordination von Armen und Beinen nicht immer auf Anhieb gelingt. Aufdrängen mag er sich jedoch nicht. Nur wenn er sieht, dass jemand mit der Technik hadert, fragt er nach, ob er einen Rat geben kann. Denn es heisst zwar: Wer gehen kann, kann auch langlaufen. Aber ganz so einfach ist es doch nicht.
Gian Flurin Pfäffli weiss, wie wichtig die richtige Haltung beim Langlaufen ist. Als Spitzensportler optimiert auch er seinen Stil stetig. «Man kann sich schnell ver-
krampfen, wenn man die Bewegungsabläufe nicht harmonisch ausführt und dadurch in ein hohles Kreuz verfallen oder einen Buckel machen. Für einen gesunden Rücken ist es deshalb wichtig, dass man den Schulterbereich aktiv öffnet.» Das erreicht man insbesondere mit dem klassischen Stil. Mit der sanften Ausdauersportart trainiert man nicht nur den Rücken und die Beine, auch Arme, Bauch- und Schultermuskeln profitieren dank dem Stockeinsatz. Und natürlich wird dabei auch Kraft, Ausdauer, Schnelligkeit und Gleichgewicht trainiert.
Ideal, dass man beim Langlaufzentrum Pontresina flache Rundstrecken vorfindet, die den Einstieg erleichtern, aber trotzdem abwechslungsreich sind. Zudem hat es tolle Übungspassagen, um Auf- und Abstiege zu trainieren. Zur späten Stunde wird die CuntschettRunde zur Nachtloipe und ist in der Saison von 17 bis 21 Uhr beleuchtet. Auch wer mit dem Hund unterwegs ist, findet entsprechend markierte Loipen.
Sobald man sich auf den schmalen Skiern sicher fühlt, kann man schon bald auf mehrheitlich ebenem Gelände Richtung Celerina oder Samedan gleiten und die Weite des Tals geniessen. «Es lohnt sich, auch einmal anzuhalten und ganz bewusst die Umgebung wahrzunehmen», gibt Langlauf-Sportler Pfäffli mit auf den Weg. Wer seinen Körper etwas mehr fordern möchte, der findet in den Seitentälern um Pontresina genügend Abwechslung. Zum Beispiel auf der Morteratsch-Loipe, die im ersten Teilstück einiges an Kondition erfordert. Hat man das Dorf hinter sich gelassen, gleitet man dann mehrheitlich eben der Bernina-Gruppe entgegen. Wer beim Restaurant Morteratsch noch genügend Kräfte hat, nimmt die Anschlussloipe zum Morteratsch-Gletscher unter die Latten. Noch etwas mehr Ausdauer braucht man auf der Roseg-Loipe, die beim
Bahnhof startet und in stetiger Steigung bis zum Restaurant Roseg führt. Dabei läuft man entlang dem gefrorenen Fluss durch eine prachtvolle Winterlandschaft mit offenen Wiesen und Lärchenwäldern. Wer dazwischen eine Verschnaufpause einlegt, entdeckt vielleicht am gegenüberliegenden Hang Wildtiere. Der Rückweg nach Pontresina ist weit weniger anstrengend und erlaubt, das Tal und die Bergwelt nochmals aus anderer Perspektive zu betrachten.

1. Nur mit intaktem Material auf die Loipe.
2. Die richtige Technik ist das A und O. Es lohnt sich, sich fachkundig anleiten zu lassen, damit das Langlaufen Spass macht.
3. Die Bewegungen gross und korrekt ausführen.
4. Mit dem richtigen Tempo unterwegs sein. Gleiten statt hetzen.
5. Sich Zeit nehmen und die Natur des Engadins geniessen.

Es lohnt sich, die richtige Technik unter fachkundiger Anleitung zu lernen, damit das Langlaufen Spass macht.

Dörfer und Landhäuser wirken englisch, doch in den Gärten wachsen Palmen. Die 14 Kanalinseln, von denen Jersey und Guernsey die grössten sind, befinden sich auf der Höhe der Normandie und bekommen viel Wärme und Sonne ab.
Artur K. Vogel
Alles wirkt sehr britisch: Typische Landhäuser und Gehöfte säumen die Landstrassen. In den Dörfern stehen steinerne Kirchen, umgeben von Friedhöfen mit schiefen Steinkreuzen. Die Insel Jersey mit 120 Quadratkilometer ist kleiner als Appenzell Innerrhoden, aber mit mehr als 100 000 Einwohnern dicht besiedelt. Noch etwas enger geht es in Guernsey zu, nur halb so gross wie Jersey, aber von rund 60 000 Menschen bewohnt. Winzig sind hingegen die weiteren bewohnten Kanalinseln Alderney (8 Quadratkilometer), Sark (5,5 Quadratkilometer) und Herm (2 Quadratkilometer). Der Rhythmus des Lebens ist beschaulich. Die Höchstgeschwindigkeit ausserorts beträgt auf Jersey 40 Meilen oder 64 km/h. Die Landstrassen sind eng, schlängeln sich vorbei an gepflegten Hecken und Steinmauern, durch Dörfer und Felder, auf denen die kleinen Jersey-Kühe grasen. Gar keine Autos gibt es auf Sark (500 Einwohnende) und auf Herm, nur ein paar Traktoren, Pferdefuhrwerke und Fahrräder.
Um sich auf Jersey fortzubewegen, ist ein Mietwagen ideal. Aber da die Insel relativ flach und nicht sehr gross ist (der höchste Punkt liegt auf 136 Metern), kann man sie auch mit Mietvelos oder zu Fuss auf herrlichen Wanderwegen erkunden. Zumal rund 80 km kleine, verkehrsberuhigte Strassen und Wege als «Green Lanes» ausgeschildert sind. Auf ihnen darf höchstens 24 km/h gefahren werden; Wanderer*innen, Fahrradfahrer*innen und Reiter*innen haben Vortritt.
Spektakulär sind Jerseys Küsten, vor allem, wenn man sie mit Trudie Trox erkundet. Trudie, in Augsburg geboren, später in München im Verlagswesen tätig, kam als Touristin auf die Insel und blieb der Liebe wegen. Zusammen mit ihrem Mann Derek Hairon betreibt sie die Jersey Kayak and Walk Adventures. Eine Wattwanderung mit ihr vom Hafen von La Rocque hinaus zum Seymour Tower erweist sich als grossartige Lektion in Botanik und Zoologie, Geschichte und Gesellschaftskunde.
Allein Trudies Story darüber, wie das Abernten von Seetang bei Ebbe oder die Austernzucht zu Wohlstand und Clan-Fehden führten, könnte ein Buch füllen. Beredt schildert sie die Tücken der Flut: Die Kanalinseln liegen vor einem Flaschenhals, wo sich der Atlantik in den Ärmelkanal zwängt. Der Unterschied zwischen Ebbe und Flut ist deshalb hier so gross wie kaum irgendwo sonst. An der Plémont Bay am nordwestlichen Zipfel der Insel zu erleben, wie sich die wilden Wassermassen tosend und Gischt aufsprühend an den Felsen brechen, ist ein eindrückliches Schauspiel. Zwischendurch ein Abstecher in die winzige Bucht von Rozel, wo in der Imbissbude «Hungry Man» seit 1947 das beste Krabbensandwich weit und breit serviert wird. Natürlich gibt es auch in Jersey Michelin-Restaurants, in denen vornehme Menschen, die vom diskreten Finanzplatz profitieren, vornehm tafeln. Strandkneipen jedoch sind viel exklusiver: Im Portelet Bay Café etwa wird ein Salat mit Jakobsmuscheln serviert, die am selben Nachmittag noch fröhlich gelebt haben.
Weltoffen und freundlich
Man begegnet hier Menschen, die weltoffen und freundlich sind: Vincent Obbard (76) etwa ist der Seigneur von Samarès Manor, einem herrschaftlichen Anwesen mit einem sorgsam gepflegten Park, in dem sich Familien tummeln, Touristengruppen, Liebespärchen. Die Seigneurs waren einst Lehensnehmer der Krone und lebten von den Abgaben ihrer Untertan*innen. Der heutige Seigneur von Samarès, der 45. in einer langen Reihe seit dem Jahr 1095, findet den Titel «irgendwie lustig», wie er sagt, aber eigentlich bedeutungslos. Er lebt von den Eintrittsgebühren der Besuchenden.

Obbard zeigt uns das weisse Manor House, in dessen Kies-Auffahrt ein alter Rolls-Royce parkt. Der Seigneur fährt danach im Bus in die Hauptstadt St. Hélier, wie er lachend beteuert. St. Hélier übrigens ist der einzige Ort auf den Kanalinseln, um den man gern einen Bogen macht. Hier ist offensichtlich zu viel Geld vorhanden, was dazu geführt hat, dass die Stadt mit protzigen Bürobauten verschandelt worden ist.
Da fährt man lieber hinaus nach St. Mary im Norden und lässt sich die La Mare Wine Estate zeigen. Dort wird nicht nur Wein produziert, was einigermassen überraschend ist für eine Gegend so weit nördlich. Auch Apfelwein, Gin, Brandy, Schokolade, Konfitüren, Karamell und Bier werden hier gemacht. Wenn Jersey ein britisch-mediterraner Mikrokosmos ist, dann ist La Mare ein Mikrokosmos der Insel Jersey, wie man sie gern in Erinnerung behält.
Reisen buchen beim Neuhauser Kanalinseln-Spezialisten rolf meier reisen: www.rolfmeierreisen.ch (bietet zwischen 13. Mai und 19. August 2023 direkte Charterflüge nach Jersey und Guernsey). Anreise im Winter: British Airways täglich ab Zürich und Basel via London Heathrow. www.jersey.com und www.visitguernsey.com
Walk Adventures: www.jerseywalkadventures.co.uk


Kandersteg
Ruhe und Rückzug nicht nur für Brüder und Schwestern: In diesen Schweizer Klöstern können Besucher*innen am entschleunigenden Alltag hinter altem Gemäuer teilnehmen.
Benjamin Haltmeier und Zora Innig
Wie könnte es auch anders sein? Es war der so bekannte wie umtriebige Walliser Unternehmer und Politiker Kaspar Stockalper, der das Briger Kloster St. Ursula gründete. Mitte des 17. Jahrhunderts wohnten die ersten Schwestern, die Ursulinen, noch in seinem prächtigen Barockschloss. Doch schon bald entstand zu Füssen des Simplonpasses eine eigenständige Ordensgemeinschaft. Heute gehört zum Klosterbetrieb nicht nur religiöse Bildung: Das zugehörige Gästehaus landete im Schweizer Hotelrating 2022/2023 unter den 100 besten Häusern. Wer in die ruhige Altstadtregion reist, kommt also nicht nur wegen der umliegenden Alpengipfel und des grossen Gartens zur Ruhe. St. Ursula ist ein Ort der Stille und des Friedens, der zum Innehalten, zur Entschleunigung und zur Besinnung einlädt. In den Kursräumen des Gästehauses fördern Angebote das Wohlbefinden, die Achtsamkeit und die Zufriedenheit der Gäste.
www.st-ursula.ch
www.brig-simplon.ch
Gastfreundschaft spielt seit jeher eine wichtige Rolle im Solothurner Benediktinerkloster Mariastein. Das liegt zum einen daran, dass das Areal schon im Mittelalter als Wallfahrtsort diente – wegen der vielen Besucher*innen musste im 17. Jahrhundert ein Gästehaus gebaut werden. Zum anderen ist das Kloster auch bei Pilgernden beliebt; schliesslich liegt es am Drei-Seen-Weg, einem der Schweizer Jakobswege. Egal, ob es nun religiöse oder weltliche Gäste sind; die einzigartige Atmosphäre Mariasteins lässt sich auf verschiedene Weise erleben. Aussenstehende werden von den Benediktinermönchen an den Tisch, zum Dialog und auf Wunsch auch zum Gebet geladen. Der Aufenthalt in Stille und Geborgenheit lässt sich mit dem Besuch einer Veranstaltung abrunden, und im Rahmen von Exerzitien und Kursen können sich auch Anfänger*innen in die christliche Spiritualität einüben.
www.kloster-mariastein.ch
www.solothurn-city.ch


Kapuzinerkloster Rapperswil
3. Kapuzinerkloster Rapperswil
Eine grüne Halbinsel am Zürichsee? Eine Lage direkt neben dem Hafen? Helle, warme Zimmer mit schönem Ausblick? Es gibt definitiv schlechtere Standorte für ein stilles Refugium. Das ist nicht nur den Kapuzinern des Klosters Rapperswil bekannt. Viele Gäste kommen zum wiederholten Mal hierhin. Seit 25 Jahren trägt die Anlage entsprechend den Titel «Kloster zum Mitleben». Hier gibt es Angebote vom täglichen gemeinsamen Nachtgebet über geistliche Begleitung bis zur Meditation am Mittwoch. Wer dafür kürzere Zeit in der Gemeinschaft weilen möchte, nutzt die Zeitfenster von Donnerstag bis Sonntag. Klassischerweise verbringen Besucher*innen aber eine volle Woche am See. Es gibt weiter auch die Möglichkeit, noch länger im Kloster zu bleiben – für mehrere Wochen oder gar monatelange Aufenthalte lohnt es sich, im Vorfeld das Gespräch mit den Brüdern zu suchen.
www.klosterrapperswil.ch
www.st.gallen-bodensee.ch
Abtei Altenryf
Der markante Sandsteinfelsen in einer Schlaufe der Saane hat diesem Kloster seinen Namen gegeben: Altenryf, auf Französisch Hauterive, geht auf das lateinische «Alta ripa», «Hohes Ufer», zurück. Hier, sieben Kilometer von Freiburg entfernt, wohnen etwa 20 Zisterzienser-Mönche im Zeichen von Gebet, Arbeit und brüderlichem Leben. Klar, gehören Zurückgezogenheit und Kontemplation zu ihrem Alltag. Die Mönche freuen sich aber stets über Gäste, die für einige Zeit an ihrer Lebensweise teilnehmen wollen. Dafür sollte man zwischen Dienstag und Sonntag mindestens drei Übernachtungen einplanen. Dabei zeigt sich das Westschweizer Kloster an der Sprachgrenze auch offen für Gäste anderer Konfessionen. Diese können auch an den von den Mönchen gesungenen Gottesdiensten teilnehmen und gegen einen bescheidenen Unkostenbeitrag von Kost und Logis in der bemerkenswerten, mittelalterlichen Anlage profitieren.
www.abbaye-hauterive.ch
5. Dhammapala, Kandersteg
Orte spiritueller Übung gibt es auch ausserhalb der traditionellen Schweizer Klöster. Beispielsweise in der kleinen Klostergemeinschaft Dhammapala, die im bernischen Kandersteg der Tradition des frühen Buddhismus nachlebt. Mönche und Novizen sowie ab und zu Nonnen meditieren in der Abgeschiedenheit der Bergwelt. Aber auch Gäste sind willkommen: Sie finden dort einen Zufluchtsort ausserhalb weltlicher Geschäftigkeit und Betriebsamkeit, indem sie mit den ansässigen Ordensmitgliedern ein Leben der Meditation, des Studiums und der Arbeit teilen. Wer das Kloster Dhammapala das erste Mal besucht, nimmt an einem Meditationskurs teil; danach sind längere Aufenthalte möglich. Die Tage beginnen um 5.30 Uhr mit der Morgenmeditation und enden nach dem Chanting und der Meditation von 19.30 Uhr. Elektronische Geräte werden während des Aufenthaltes ausgeschaltet – Abschalten ist also im wörtlichen Sinne garantiert.
www.dhammapala.ch www.madeinbern.ch






Info-Abend: 11. Jan.
3 Jahre, ASCA u. SGfB-anerk

Info-Abend 24. Jan
3 Jahre, ASCA u. SGfB-anerk
«Ihr Aus- und Weiterbildungsinstitut IKP: wissenschaftlich –praxisbezogen – anerkannt.»
Neu: Finanzierung Ihrer Ausbildung durch Bundesbeiträge Mit Option zum eidg. Diplom
Körperzentrierte/r Psychologische/r Berater/in IKP Psychosoziale Beratungskompetenz kombiniert mit Körperarbeit (Erleben und Erfahren über den Körper), Entspannungsübungen, Sinnfindung und Ressourcenstärkung.
Ernährungs-Psychologische/r Berater/in IKP Angewandte Psychologie: Fundierte, praxisnahe Kompetenzen in Ernährung und Psychologie, mit welchen Sie Menschen mit Ernährungsproblemen ganzheitlich und lebensnah beraten.
Beide Weiterbildungen können mit einem eidg. Diplom abgeschlossen werden. IKP Institut, Zürich und Bern
Seit 40 Jahren anerkannt

Mehr als 500 Kurse, durchgeführt von erfahrenen Fachdozenten.

Faszien in Bewegung

Faszientraining Beckenboden
PREMIERE: Natürlich Heilen mit FREIEN ENERGIEN.
Infoabend 12.01.2023. www.waschbrett-lady.ch

Neuroathletik Basic –Training des Nervensystems

Nahrung fürs Blut –Eisen, Vitamin B12, Folsäure und Co.



Shaolin Power Qi Gong Manualmedizinische Manipulations- und Mobilisationstechniken
Fasten. Gesundheit. Auszeit.

Wo Sie statt Meerblick mehr Blick haben.
Im Kurhaus St. Otmar blicken Sie aus dem Fenster und sehen mehr als Meer. Bewusst wahrnehmen, weil Fasten Ihre Sinne schärft. Bewusst erleben, weil Sie Zeit haben zum Sein. Fastenkuren in St. Otmar – Ihre Mehrzeit
Kurhaus St. Otmar · 6353 Weggis · www.kurhaus-st-otmar.ch

WEITERBILDUNG
18. März bis 25. November 23, 8 Tage mit Domenica Meier-Durisch.
Viele Personen stossen in ihrer Arbeit regelmässig auf das Thema Trauer und manchmal dabei auch an ihre Grenzen. Das Ziel der Seminarreihe ist, das Thema in der Gesellschaft zu enttabuisieren und Menschen dabei zu unterstützen, einen guten Umgang mit Verlust und Trauer, mit sich selber und ihrer Umwelt zu erlernen. Der Zyklus darf als Ganzes zum Zertifizierten Trauerbegleiter oder als Tagesthema einzeln gebucht werden.
LIKA GmbH, Stilli b. Brugg, 056 441 87 38, www.lika.ch

WOHLFÜHLEN UND GENIESSEN
In der Casa Santo Stefano finden auch im Jahr 2023 wieder viele interessanten Yogakurse, Fastenwochen, Kochkurse etc. statt. Gönnen Sie sich Entspannung und Genuss in einem speziellen Ambiente.
25.2. – 03.3. Fasten & Yogawoche
05.3. – 11.3. Fasten & Klangwoche
11.3. – 17.3. Yoga & Wanderferien
19.3. – 25.3. Yoga & Intervallfasten
25.3. – 30.3. Yoga & Wanderferien
02.4. – 06.4. Yogatage
10.4. – 16.4. Intensiv-Yogaretreat
16.4. – 21.4. Yogaferien
23.4. – 28.4. Yoga & Wanderferien
06.5. – 11.5. Yoga & Pilates
Casa Santo Stefano, Miglieglia 091 609 19 35 | casa-santo-stefano.ch

FENG-SHUI
Wandbilder für ein harmonisches Fliessen der Lebensenergie
Die Wandbild-Gestaltungen von Anima Pura beruhen auf Feng-ShuiGrundsätzen. Sie bringen die Atmosphäre eines Raumes in ein gutes Gleichgewicht und erleichtern ein harmonisches Fliessen des Qi. Mit ihren klaren Formen und Farben wirken sie unaufdringlich und fein. Anima Pura-Wandbilder eignen sich für Räume für Therapie, Erholung, Meditation und zum Wohnen.
Lassen Sie sich inspirieren auf: www.anima-pura.ch

SCHEIDENPILZ
Drei von vier Frauen sind mindestens einmal in ihrem Leben von einer vaginalen Pilzinfektion betroffen. Kadefemin® myocostop kann die typischen Symptome wie Juckreiz, Rötungen und veränderten Ausfluss lindern. Rezeptfrei erhältlich in Apotheken und Drogerien. Dies ist ein zugelassenes Arzneimittel. Lesen Sie die Packungsbeilage.
Max Zeller Söhne AG, 8590 Romanshorn, www.zellerag.ch

WECHSELJAHRE
Zeller wechseljahre/forte ist ein pflanzliches Arzneimittel mit einem Extrakt aus Traubensilberkerze. Es wird eingesetzt gegen Wechseljahrbeschwerden wie: Hitzewallungen, Schweissausbrüchen, Schlafstörungen, Nervosität und Verstimmungszuständen.
Dies ist ein zugelassenes Arzneimittel. Lesen Sie die Packungsbeilage.
Max Zeller Söhne AG, 8590 Romanshorn

Burgerstein Vitamine – Feiern Sie mit uns das 50-Jahre-Jubiläum!
Alle Informationen zu unserer Firmengeschichte finden Sie hier:
Lösung des Rätsels aus dem Heft 11/2022 Gesucht war: Schutzengel
Vorname Name
Strasse PLZ / Ort
Lösung

Und so spielen Sie mit: Senden Sie den Talon mit der Lösung und Ihrer Adresse an: Weber Verlag, «natürlich», Gwattstrasse 144, 3645 Gwatt Schneller gehts via Internet: www.natuerlich-online.ch/raetsel



Teilnahmebedingungen: Einsendeschluss ist der 23. Januar 2023. Die Gewinnerinnen und Gewinner werden direkt benachrichtigt. Eine Barauszahlung ist nicht möglich. Über diese Verlosung wird keine Korrespondenz geführt. Der Rechtsweg ist ausgeschlossen.
Gewinnen Sie eine von 10 Burgerstein Vitamine-Geschenkboxen im Wert von je 150 CHF Die Geschenkboxen enthalten eine Auswahl unserer beliebtesten Burgerstein Vitamin-Produkte für die ganze Familie.

IMPRESSUM
41. Jahrgang 2022, ISSN 2234-9103 Erscheint 10-mal jährlich Druckauflage: 22 000 Exemplare Verbreitete Auflage: 20 182 Exemplare (WEMF/KS beglaubigt 2022)
Kontakt
mail@natuerlich-online.ch, www.natuerlich-online.ch
Redaktion, Herausgeber und Verlag
Weber Verlag AG , Gwattstrasse 144, CH-3645 Thun Tel. +41 33 336 55 55, leserbrief@natuerlich-online.ch www.weberverlag.ch
Verlegerin
Annette Weber-Hadorn a.weber@weberverlag.ch
Verlagsleiter Zeitschriften
Dyami Häfliger d.haefliger@weberverlag.ch
Chefredaktor
Samuel Krähenbühl, s.kraehenbuehl@weberverlag.ch
Leser*innenberatung
Sabine Hurni, s.hurni@weberverlag.ch
Weitere Autor*innen
Samuel Krähenbühl, Fabrice Müller, Sabine Hurni, Therese Krähenbühl, Markus Kellenberger, Nicole Rapin, Leila Dregger, Lioba Schneemann, Steven Wolf, Andreas Walker, Gabriela Gerber, Elisha Nicolas Schuetz, Silvia Schaub, Artur K. Vogel, Benjamin Haltmeier, Zora Innig, Eva Rosenfelder
Grafik/Layout
Shana Hirschi, Nina Ruosch
Copyright Nachdruck, auch auszugsweise, nur mit Genehmigung durch den Verlag. Für unverlangte Einsendungen wird jegliche Haftung abgelehnt.
Anzeigenleitung
Dino Coluccia, Tel. +41 76 324 64 45 d.coluccia@weberverlag.ch
Anzeigenadministration/Marketing
Blanca Bürgisser, Tel. +41 33 334 50 14 b.buergisser@weberverlag.ch
Mediadaten unter www.natuerlich-online.ch/werbung
Aboverwaltung abo@weberverlag.ch, Tel. 033 334 50 44
Druck
Vogt-Schild Druck AG, CH-4552 Derendingen
Bildnachweise
Andrea Abegglen: Seiten: 3, 26
Therese Krähenbühl: Seiten: 20-23
Sonja Berger: Seiten: 36-39
Andreas Walker: Seiten: 46-47
Tourismus Adelboden-Lenk-Kandersteg: Seite: 60 Rapperswil Zürichsee Tourismus: Seite: 61
Fabien Jaquier: Seite: 61 Johannesbad Bad Füssing Seiten: 54, 55
Leonie Lorenz: Seite: 55
ABONNIEREN
Einzelverkaufspreis Fr. 9.80
Abonnement 1 Jahr Fr. 89.–Abonnement 2 Jahre Fr. 159.–
Preise inkl. MwSt. www.natuerlich-online.ch/abo

Was unsere Augen über die Gesundheit verraten.
Die Augen als Fenster in unsere Seelen.
Trockene Augen. Was lässt unsere Augen austrocknen und was können wir dagegen tun?
Inhalieren. Erkältungen mit Dampf und Kräutern zu Leibe rücken
Superfood Kohl. Das gesunde Lagergemüse neu entdeckt und gestaltet.
«natürlich» 01-02/23 erscheint am 26. Januar 2023
Kontakt /Aboservice: Telefon 033 334 50 44 oder abo@natuerlich-online.ch, www.natuerlich-online.ch
Eva Rosenfelder
Raureif schmückt Halme und Sträucher. Trotz Winterfrische will ich einfach nicht recht wach werden, zu schön war es unter der warmen Bettdecke. Andere halten schliesslich auch Winterschlaf! Wieviel Larven schlummern wohl hier in Käferbohrlöchern, Markstängeln oder im Erdboden? Fast meine ich, all die kleinen Wesen in ihrem stillen Dasein wahrzunehmen …
In Tat und Wahrheit ist dieses «süsse Schlummern» für viele Insekten und Wildtiere eine riesige Herausforderung, bis zum Frühling überleben zu können. Eine Vielzahl von Arten beendet ihren Lebenszyklus innerhalb eines Jahres, so etwa solitär lebende Wildbienen, aber auch soziale Arten wie z. B. die Hummeln. Manche Schmalbienenarten haben sogar mehrjährige Entwicklungszyklen und oft kaum Chancen, diese zu vollenden. Auf Ertrag ausgerichtete landwirtschaftliche Nutzflächen, menschliche Gartenaktivitäten wie eifrige Gartenscheren zum falschen Zeitpunkt, generelle «Aufräumeritis» beenden abrupt und meist unwissentlich das Leben so mancher Insektenbrut.
Wildbienen legen ihre Eier im Frühling an geeigneten Brutplätzen ab. Jede Zelle versorgen sie sorgfältig mit Proviant, verschliessen sie, um sie dann sich selbst zu überlassen. Bald nach der Eiablage entwickeln sich die Larven, die sich schon nach wenigen Tagen in der Zelle verpuppen. Dann aber wird entschleunigt und die Puppe verweilt über den ganzen Winter in diesem Stadium. Fast 9 Monate – also den grössten Teil ihres Lebens – verbringen Wildbienen als Larven in Pflanzenhohlräumen, Baumhöhlen etc. Erst im nächsten Frühling bis Frühsommer schlüpfen die Jungtiere aus ihrer Brutzelle ans Licht, um sich zu paaren, den Bestand zu sichern, und nach der Eiablage im Sommer zu sterben – ein neuer Zyklus beginnt.
Viele Arten wie etwa Stängelnister sind darauf angewiesen, dass Pflanzenstängel mehrere Jahre erhalten werden. Im ersten Jahr blüht die Pflanze und verdorrt

im Herbst. Erst im zweiten Jahr nisten Wildbienen darin, schlüpfen dann im dritten Jahr … Weil die meisten Wildbienen ortstreu sind, brauchen sie Nistplätze, die über mehrere Jahre hinweg sich selbst überlassen werden. Ein kleiner Teil Wildnis im Garten, auf dem Feld als Geschenk für diese Kleinlebewesen?
Gedankenverloren betrachte ich einen alten, hohlen Baum voller Bohrlöcher und Spinnennetze – entdecken kann ich zwar «niemanden», doch bestimmt haben sich hier überwinternde Falter, Fledermäuse oder gar Siebenschläfer verkrochen? Vielleicht schlummern im feuchten Erdreich hier auch Erdhummeln, Kröten oder Molche? Alle geben sie sich der Winterruhe und Starrheit hin, verharren geduldig, sammeln Kraft für neues Erwachen im Frühling. Getragen vom Naturkreislauf schöpfen sie diese immer wieder frisch, übergeben ihre Nachkommen vertrauensvoll dem Leben selbst.
Verstecke, ein Unterschlupf zum Brüten und Überwintern, das können Laub-, Ast- und Steinhaufen, Pflanzenstängel, ein Stapel Blumentöpfe, Kletterpflanzen sein – einige unberührte Winkel und schon kreucht und fleucht es. Auch uns – der Spezies Mensch, die wir nicht mehr und nicht weniger als nur ein Teil dieses erstaunlichen Naturnetzes sind – würden natürliche Schutz- und «Brut»-räume mehr als nur guttun! Die Stille der dunklen Jahreszeit ist wie gemacht, um in sich zu lauschen und Lebenskraft zu schöpfen, die sich mit dem erwachenden Frühling in neuen Projekten und Inspirationen verwirklichen darf. So trolle ich mich also getrost hinter die Ofenbank, um zu erträumen, was alles noch ans Licht wachsen wird.
Eva Rosenfelder ist Autorin/Journalistin BR. In ihrer Serie schreibt sie über kleine und grosse Glücksmomente des Alltags. Mehr über die Autorin und ihre Angebote erfahren Sie unter www.natur-und-geist.ch
Keine
Bea-Punkte?
Kein problem!



























Nur ausgesuchte, beste Zutaten für ihre Hautpflege













Kann in ausgewählten Apotheken und Drogerien nachgefüllt werden.
Tentan AG, 4452 Itingen • www.eduardvogt.ch